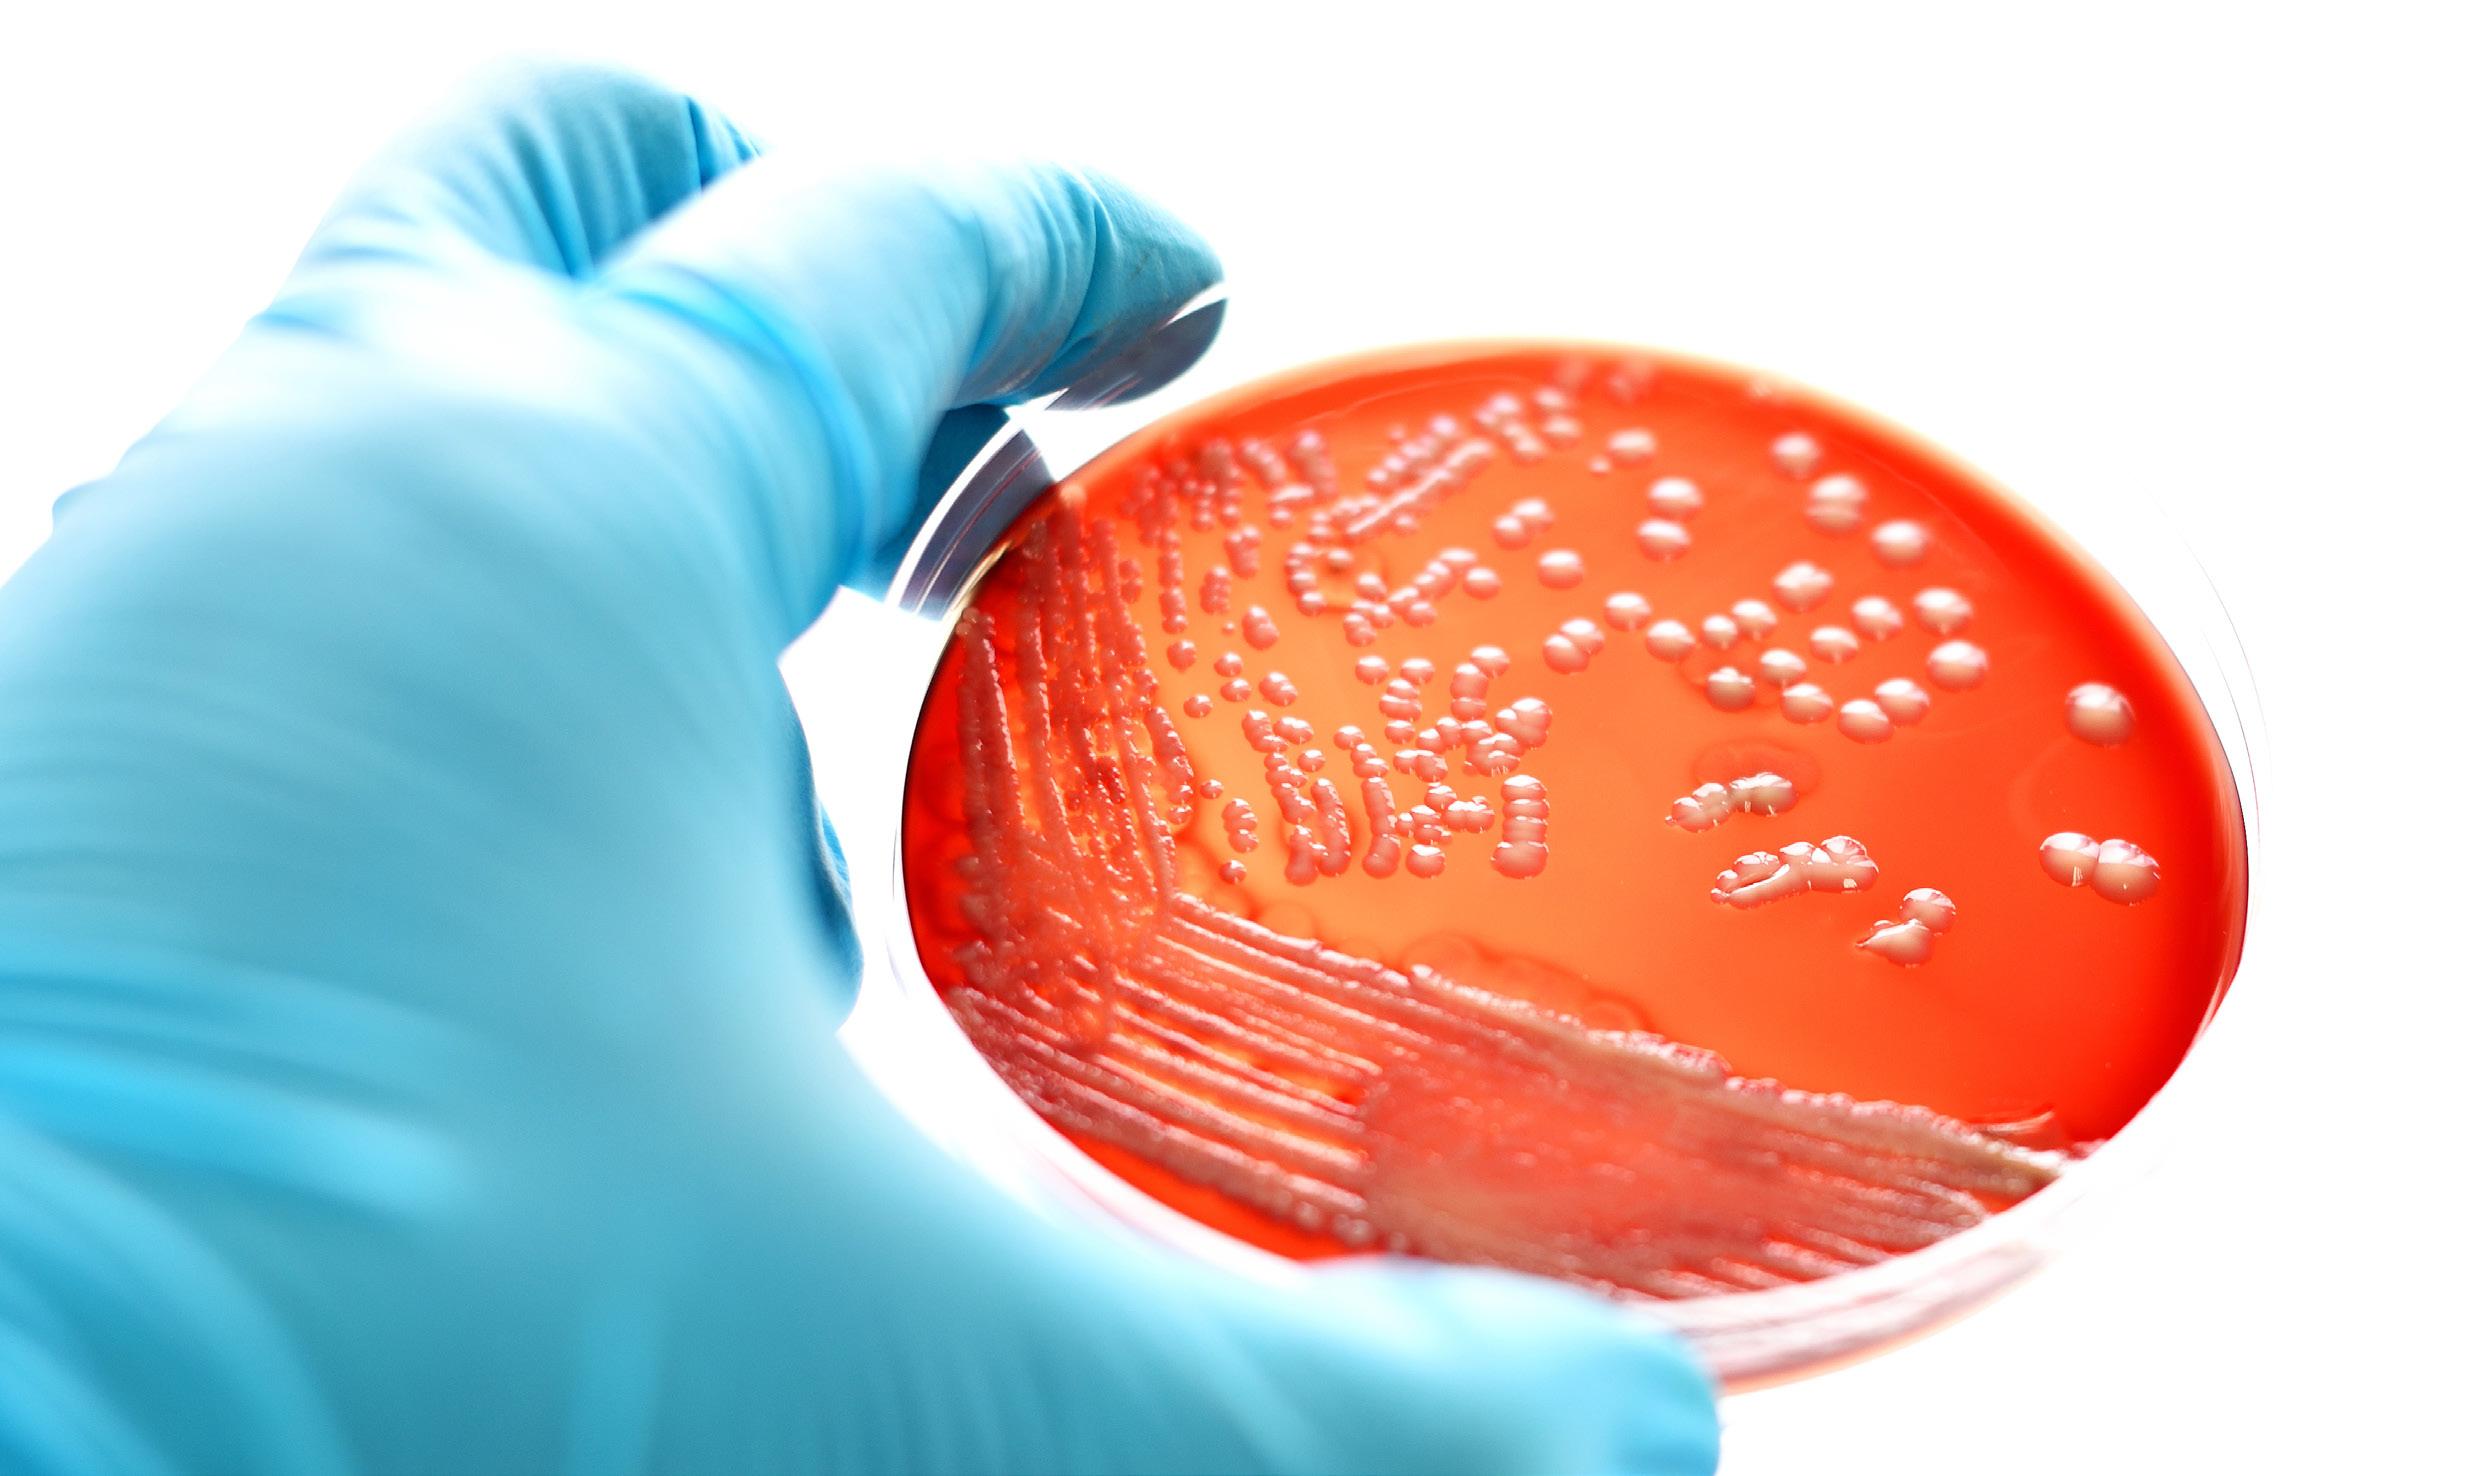
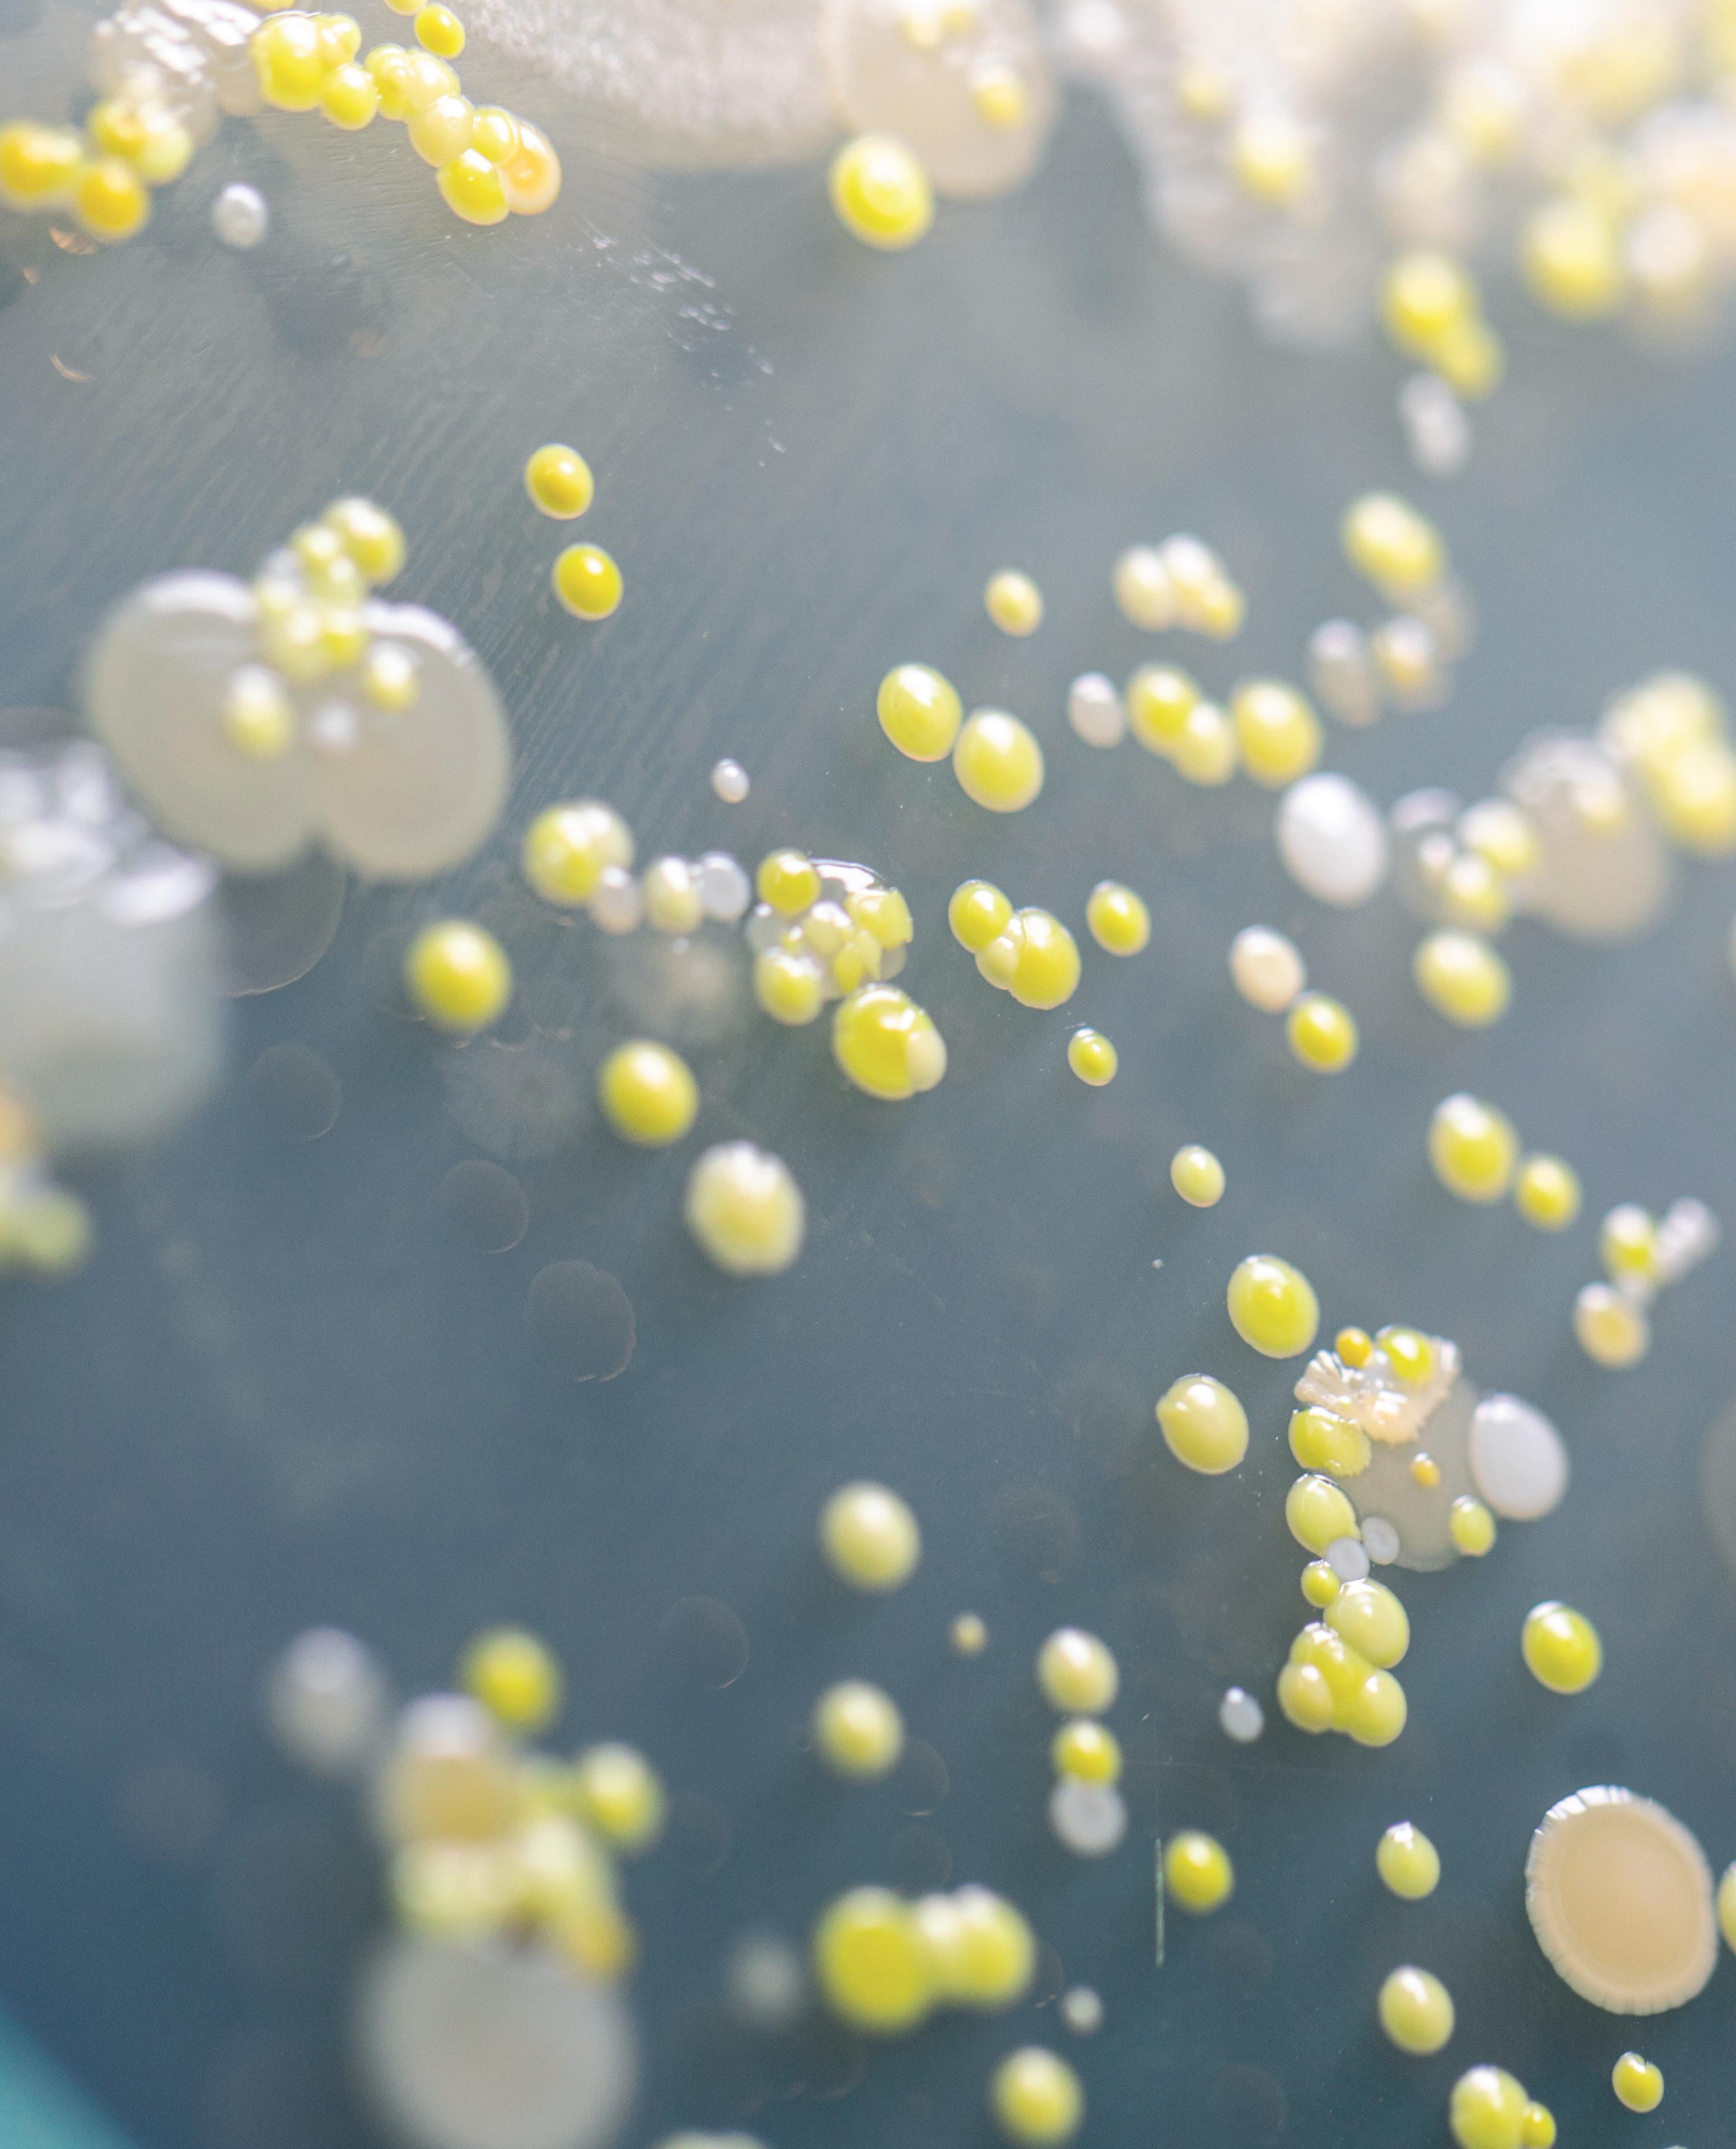

Udstyr til naturlære 2023-24






Fair pris-konceptet
Priserne går op og op, i hvad der ligner en evig himmelflugt. Derfor arbejder vore dygtige indkøbere konstant med at indkøbe smartere og billigere - og gerne mere lokalt, der hvor det giver mening. Vi sætter gern kvaliteten op uden at prisen ryger med.













Med “fair pris” symbolet fejrer vi de små sejre. Er varen blevet billigere for os, så bliver den billigere for vores kunder.

Derfor ser du heller ikke vilde tilbudsaviser og udsalg hos Scandidact. Varen koster det den koster - indtil den bliver billigere for os i indkøb.
Det synes vi er mest fair.






Hold øje med sparegrissymbolet og se, når vi fejrer, at vi har indkøbt smartere og billigere...
- for os og for jer!
Scan QR koderne i kataloget med kameraet eller QR-app’en på din smartphone og hent GRATIS øvelsesvejledninger










Biologi 3 Geografi og miljø 38 Fysik 54 Kemi og laboratorieudstyr 58
Biologi

Vand- og jordanalyse


JBL Saltvands-testkuffert
Overvåg nemt vandværdierne i saltvandsmiljøer med denne praktiske kuffert, der indeholder alt hvad I skal bruge til at udføre 11 tests af f.eks. værdierne for pH, carbonathårdhed, calcium, magnesium, kobber, ammonium, nitrit, nitrat, phosphat, silikat, ilt m.m..
Det er utrolig let at bruge sættet, hæld blot vand i kuvetten, tilføj indikator, sammenlign på skala / tæl dråber, indtil farven ændrer sig. Sammenligningssystemet tager hensyn til vandets naturlige farve.
Der medfølger i alt 29 reagenser, 12 glasbeholdere, 2 plastikkuvetter, 2 sprøjter, 3 måleskeer, termometer, pen, rapport- og analyseark, samt udførlig vejledning til både folkeskole og stx-niveau.
Sættet kan efterfølgende genopfyldes enkeltvis.


JBL Saltvands-testkuffert basic
Simpel saltvands-testkuffert til analyse af pH, fosfat, carbonathårdhed, ammoniak, ammonium, nitrit og nitrat.






PRISER FRA KR. 179,-

Bestemmelses- og sorteringsduge

Danmarks største udvalg! Sid og gå på den - tør blot ren med en våd klud.
>> Smådyr i de ferske vande

>> Vandløbsbestemmelse
>> Planter fra sø og dam
>> Saltvandsdyr
>> Tang
Transportrør

>> Smådyr/insekter fra landjorden



>> Sten ved stranden
>> Sortering af sten
>> Sten/ledeblokke
>> Planter fra sø og dam
>> Skovens træer om vinteren
>> Skovens forårsblomster



>> Skovens svampe
Raunkiærs cirkler
Praktisk transport af bestemmelsesduge mv. i dette opbevaringsrør, der er monteret med praktisk justerbar bærestrop.
Raunkiær cirkel (1/10 m til statistisk undersøgelse af kvantitativ flora- og faunaforekomst.
OBS: nu i rustfrit stål!
>> Dyrenes stamtræ


>> Evolution og klassifikation

Gå på opdagelse i sø og å
Bestemmelsesdug
- planter fra sø og dam
Praktisk bestemmelsesdug i farver trykt på en kraftig vinyldug med pædagogisk inddeling og detaljerede illustrationer. Dugen måler 110 x 110 cm.
Vandløbsbedømmelse - bog og dug
Populært feltværktøj udarbejdet af Eigil Holm. 60 siders bedømmelsesbog i farver til brug sammen med bedømmelsesdugen af samme navn.
Bog Dug
Waders




Komfortable waders med god slidstyrke, refleksstriber på ben, fixlock-lukning, sømværn og ståltåkap.
Scan QR koden med kameraet på din smartphone og hent GRATIS


øvelsesvejledning til indsamling af vandplanter
Sø og å, plakat
Smuk naturplakat med de mest almindelige dyr og planter der lever i søer og åer.
Vælg mellem: A2 A4
Waders ophæng

Løs udfordringen med opbevaring og tørring af dine waders med vores ophæng.
Til 1 par


Til 2 par

6
Plastakvarier, flere størrelser
Akvarium/terrarie/faunaboks med håndtag og foderlem. Velegnet til både indsamling, opbevaring og transport.

Fra 1-20 liter.


Vandhenter

Tag vandprøver fra din ønskede dybde eller fra overfladen og foretag målinger i felten eller hjemme i faglokalet. Med udløsermekanisme, 1,5 liters kammer og 15 m nylonsnor.

Sigtbarhedsplade/Secchiskive

Praktisk sort/hvid udgave på 410 g til søer uden meget strøm. Inkl. lille nøgle med 3 m kraftig fiskeline, samt plastikvindsel med 100 m nylonline.
Indsamlings- og opbevaringsglas


Firkantede af klar plast med skruelåg. Vælg mellem 50, 100, 200, 500 og 1000 mL.

7
Net, net, net...
Planktonnet 180 µm m/line


Professionelt planktonnet med 180 µm til indsamling og observation af små vanddyr. En stærk netdug er spændt ud og forstærket med bomuldsstof på en kraftig ring. Net diameter 30 cm, dybde 89 cm, plastikbeholder 5 cm dyb.

Fiskenet, Ø20 cm
Et populært net med større masker end vores dafnienet. Med forstærkende stofkant, der gør nettet mere holdbart og aluminiumsskaft på 120 cm.
Forstærkede sigtenet
120 cm skaft i asketræ, ø16 cm
150 cm skaft i asketræ, ø20 cm
Med krydsforstærkning for ekstra holdbarhed. 120 cm skaft i asketræ, ø16 cm
150 cm skaft i asketræ, ø20 cm
Dafnienet, forstærket
Klassisk dafnienet i forbedret udgave med forstærkning og et fintmasket net, der er ideelt til dafnier og andre små vanddyr. Ø20 cm, 120 cm coated bambusskaft og totallængde 140 cm.
til dine net. Måler 30 cm - svarende til ca. 20 dafnienet eller 12 fiskenet.


8
NYHED
Grejkasser
Perfekt som grejkasse til ekskursioner og forsøg i felten. De perforerede sider sikrer ventilation, så udstyret luftes og tørres og medvirker desuden til at kassen holder en forholdsvis lav vægt.

60 x 40 x 17 60 x 40 x 42
60 x 40 x 32 Låg, 60 x 40

Kasterive 40cm

Vandplanterive i rustfrit stål til indsamling af tang og vandplanter. Komplet med line på vindsel.
Krebseruse

Rudestørrelse: 17 x 20 cm.
Undgå lysets brydning i vandoverfladen og iagttag livet i vandet og på bunden – selv på større dybder. Udformet i robust plast, der holder i mange år.

Løftenet/krabbenet

Fungerer lidt ligesom en krebsebrik, men har højere sider. Måler 30cm i diameter.
OBS: Kræver lystfisketegn (dog ikke, hvis man er under 18 år eller over 65 år)
Scan QR koden med kameraet på din smartphone og hent


øvelsesvejledning til indsamling af vandplanter
Stor model Rudediameter 32 cm, højde 55 cm





9
GRATIS
NYHED
Træd ind i Phauniernes eventyrlige verden
Mød Phaunierne, undervisningssæt
Brug Phaunierne til masser af leg, læring og udvikling.
NATUR – RELATIONER – EVENTYR – SANKE – RIM – TAL – MØNSTRE – SANSER – KREA MED MAD, DRIKKE & DEKORATIONER
En Phaunie (udtales Favni) er et lille eventyrligt væsen, der bor i skove, krat og haver, i parker og på altaner. Den er ikke større end en tommeltot, og den elsker at gemme sig, men vil i virkeligheden rigtig gerne findes og bruges til noget. Lidt ligesom mennesker.
Phaunierne er små væsener, der på eventyrlig vis, passer på og sørger for alle de gratis gaver, som vi kan finde og samle i naturen, og som vi kan bruge til at lave mad, drikke og dekorationer af. Der er f.eks en Brombær Phaunie, en Æble Phaunie og en Kastanje Phaunie.
Klar-parat-pakkerne fra Scandidact inkluderer:
• Inspirationshæfte med masser af aktiviteter til ude og indendørsaktiviteter
• 12 Phaunie plakater (A5, A4 eller A3)




• 12 Phaunie kort (A6) til at tage med på tur
Varenr. SKU335
Vælg mellem:
A3-pakke
A4-pakke
A5-pakke
Mød Phaunierne, 3-i-1 kortspil
Sjovt 3-i-1 kortspil til børn. Med disse Phaunie kort kan I spi tre lette spil med de samme kort: Vendespil, Skraldeper og det sjove Fire på Phaunie. Vendespil er det samme som huskespil, og Skraldeper spilles, som klassisk Sorteper, men her er skraldekortet den store synder.
NYHED NYHED
Lupper - bringer jer helt tæt på!
Feltcontainer

Praktisk følgesvend til ekskursionen. Leveres med bærerem. Lup 5x.
Iagtagelseslup
Velegnet til ekskursioner for alle aldersgrupper. Lup 5x.

Bordlup/frimærkelup 10x
Lup med fokuseringsstøtte til frimærker, pengesedler, mønter, sten, bøger mm. Linse Ø4,1 cm, bund 5 cm.

Tovejslup

Spejle i luppen gør det mulig at se objektet fra flere sider. Lup 4x.
Foldelup dia. 21 mm. Botanikerlup med triplet linse. Lup 10x.
Lup dia. 45 mm.



Velegnet til et utal af formål - eks. som brændeglas. Lup 2,5x.
Læseglas



Let at benytte for alle aldersgrupper. Lup 2x og et mindre felt med 4x.
Zoom-mikroskop
Praktisk lommemikroskop med LED, som giver optimal belysning af genstanden. Lup 20x-40x.


11
Vild med insekter
Miniaturerne, kortspil om insekternes verden
Lad insekternes styrker dyste mod i hinanden på en ny måde i det klassiske spil 'krig'.
Insekter i Danmark


Den mest omfattende håndbog om insekter på dansk - mere end 1200 arter af insekter og leddyr er beskrevet. Arterne er vist med tegninger og oplysninger om størrelse, findetid, levested, hyppighed og andet. Bogen er forsynet med en nøgle til insekttyperne, afsnit om dyrenes opbygning og levevis, om indsamling, præparering og konservering samt et omfattende register.
Sorteringsbakke
Praktisk bakke med 15 rum, der måler 6x6 cm. Meget nyttig når fangsten af smådyr og planter fra ekskursionen skal sorteres. Lave skillevægge sikrer, at sorteringen med ske, pincet eller pensel er nem og hurtig.

Insektsuger

Til indsamling af smådyr. Man suger i den ene slange og holder den anden mod det sted, hvor smådyrene findes. Et fint net forhindrer, at man får dyr i munden.

Insektnet, Ø300 mm
Flot insektnet / sommerfuglenet i høj kvalitet på kraftig ramme og med 76 cm skaft i poleret træ.

12
Insektkasser til præparation og display

Massivt fyrretræ med aftageligt glaslåg og løs flamingobund.
Mål 15x16x6 cm.



Mål 40x30x6 cm.
Stor og flot poleret træopbevarings- og displayboks med messinglåse. Mål 45x31x7 cm.

Insektnåle, flere størrelser
Pakker med 100 stk. til montering af insekter på spilebræt/spændebræt. Forskellige størrelser til både små-insekter, blåvinger og de store ligustersværmere og guldsmede.
Vælg mellem str. 000, 0, 1, 2, 3, 4, 5, 6 og 7.
Spilebræt i mange størrelser
Spændbræt/spilebræt med skumbræmme i rillen - beregnet til montering af insekter. Vælg mellem str. 000, 0, 1, 2, 3, 4, 5, 6 og 7.


13
Flagermusdetektor D200
Lille, let og handy heterodyn flagermusdetektor med baggrundsbelyst digitalt display, der viser den indstillede frekvens. Indstilling af frekvensen og volumen justeres på siden af flagermusdetektoren, hvilket gør betjeningen enkel og let. Detektoren kan bla. tilsluttes høretelefoner.
Flagermus, USB ultralydsmikrofon
Med denne USB-mikrofon

sættes der en ny standard med fremragende følsomhed, lav støj. Trods sin lille størrelse, er det hele placeret i et slankt og slidstærkt aluminiumskabinet. Lavt strømforbrug, kombineret med en attraktiv pris gør denne model yderst populær.
Flagermusredekasse, universel
Flagermusredekasse i høj kvalitet fra tyske Schwegler. Særligt velegnet til langørede flagermus, men også en god begynderkasse, for at teste, om der er flagermus i området. Hvis flagermushuset ikke er blevet benyttet af flagermus efter nogle år, kan den let konverteres til en mejseredekasse
model 301221 blot ved udskiftning af frontpladen.

Flagermusdetektor D240X
Meget populær heterodyne og tidsekspansion-detektor med baggrundsbelyst digitalt display, der viser den indstillede frekvens i heterodyne mode. Nem regulering af frekvens og volumen på siden af detektoren. Ved hjælp af stereo hovedtelefoner, høres det heterodyne signal på den venstre kanal og tidsekspansion signal på den højre kanal.



Roland audio optager

Optag fra din flagermusdetektor og gem lydfilen til videre forarbejdning. Denne bærbare lydoptager everer lyd af den kendte høje Roland-kvalitet og en lang række praktiske optagefunktioner, når man er på farten.

14
Dissektionsdug til blåmusling

Genanvendelig dug i kraftig plast med anvisninger til dissektion. Dugen beskytter bordpladen og rengøres nemt.

øvelsesvejledning om muslingernes filtreringsevne udviklet i samarbejde med Naturpark
Lillebælt
Dissektionssæt

Komplet sæt i æske. Kan stables og tages med i felten.
Dissektionsbakke
Kraftig formstabil kvalitet. Nem at rengøre. Mål: 37 x 27 x 6 cm.

Klassesæt uden uglegylp
Sjov og underholdende videnskab lige fra uglens mund. Til undervisning i: fødekæder, økologiske principper, anatomi, fysiologi og naturhistorie. Inkluderer: teori og øvelsesvejledning, kranienøgle og 3 plakater.
Dissektionsbakke


Metalbakke med voks til at fæstne med f.eks. spilenåle.

Uglegylp, 1 stk



15
Scan QR-koden og hent GRATIS
NYHED
Vild med fugle
Redekasser
Redekasser til de mest almindelige danske fuglearter. Isolerende letbeton sikrer jævn temperatur på varme dage og kolde nætter.
Eks.
Gærdesmutte

Nordeuropas Fugle - felthåndbog
Beskriver samtlige ynglefugle og almindelige trækgæster samt sjældne strejfgæster. I alt 420 arter med over 1200 farvefotos, udbredelseskort og QRkoder med 340 fuglestemmer.
Danmarks Natur - fugle i haven




Beskriver og illustrerer 62 af de mest almindelige fugle, du kan se i din have med oplysninger om udseende, udbredelse, levevis og trækforhold.
Spurve, mejser
Gråspurvekoloni
Kikkert, 8x40
Klassisk porroprisme-kikkert med fuld antirefleksbehandling og stort synsfelt, som gør det nemt at følge dyr i bevægelse. Kan anvendes af brillebrugere, da der medfølger øjestykker.
Smukke illustrationer






Håndtegnede af danske illustratorer. Brug plakaterne som dekoration i faglokalet eller institutionen og øv jer hver dag.
Fuglefoderhus til vindue
Væk børnenes interesse for naturen - eller glæd en af dine kære, som ikke selv kan komme ud. Måske også den perfekte tilføjelse til hjemmekontoret?

Bestil varenr.:
Kystfugle SKU182
Havens Fugle SKU72

Ørne SKU71

Vild med planter
Papirstøbeform A4

Lav-selv-papir med denne støbeform med net. Genanvend papirrester, æggebakker og lign. og lav jeres eget papir. Tilsæt evt. lidt flydende akvarelmaling, velduftende blade, lavendler, pressede blomster eller måske bladguld? Måler 20 x 30 cm.
Plantepresse til feltbrug
Feltpresse af hårdttræ med nylonstropper holder pressen stramt sammen og metalklamper sikrer et stabilt og jævnt pres på planter og blomster. Mål 31 x 46 cm.
Smukke illustrationer
Håndtegnede af danske tegnere. Brug plakaterne som dekoration i faglokalet eller i hjemmet og øv jer hver dag.
Klassisk design med spænderulle i hårdt asketræ og presseplader i MDF. Ventilationshuller i pladerne nedsætter risiko for skimmel og mug og den øgede luftcirkulation giver hurtigere tørring. Rummer op til 100 stk. plantepressepapir
Eksempler:
Grøftekant SKU308
Træer SKU64
Forårsskoven SKU312
Lægeplanter SKU63
Giftige planter SKU56


Giftige bær SKU57
Hedeplanter SKU104

Træernes blade SKU123
Spiselige vilde planter SKU60
Spiselige blomster SKU108




Spiselige vilde frugter SKU59
Nåletræer SKU65
Husk at fylde lageret op med plantepressepapir, herbariepapir,
18
Svampe - lette at kende
Et svampekort til feltbestemmelse, udarbejdet som en lille og handy folder. Sammenfoldet fylder kortet 8,5 x 16,5 cm.


Rød fluesvamp


20 cm høj model af den smukke, giftige røde fluesvamp. Fremstillet håndlavet og -malet af anerkendte SOMSO ®, som producerer mange svampe og plantearter - kontakt os for flere priser.


Svampekniv med børste
Praktisk foldekniv med blød børste for enden, målestok og nøglering. Måler 17 cm udfoldet.
Birkesaft tapningssæt
Birkesaft kan tappes fra det tidspunkt safterne i birketræet begynder at stige. Det vil efter en typisk vinter være fra cirka midten af marts frem til at træerne springer ud i april. Med dette komplette sæt til tapning af birkesaft kan der tappes 4 dunke á 2,5 liter skøn, velsmagende og sund birkesaft.
Indeholder: tappespand med hank og låg med hul (10 L), 4 stk 2,5 liters plastikdunke, en meter plastslange af PVC, tappestuds i messing, 2 stk. dyvler til at lukke hullet efter tapningen.

Tapningssæt Bag-in-box pose til opbevaring
Kompostbeholder
Kompostdisplay til undervisning i biologisk nedbrydning, livscykler og miljø. 3 gennemsigtige rum gør det muligt at følge med i den biologiske nedbrydningsproces og sammenligne forskellige affaldsprodukter. Termometre viser temperaturudsving under nedbrydningen.
Jordrespirometer

Undersøg respiration, nedbrydningsprocesser og stoffernes kredsløb. Jordrespirometret kan også anvendes, som en lille fotosyntesetank, hvor man kan måle på fotosyntesen hos f.eks. karse eller andre planter.

19
NYHED
Akvarier og terrarier

Akvarium 54 L, startsæt m. LED lys
Få en succesfuld opstart i akvariehobbyen - tilsæt blot fisk, grus og akvarieplanter. Lyseffekt, varmelegeme og filterflow er valgt, så de passer perfekt til akvariernes størrelse.

Sættet inkluderer: belysning, filter, varmelegeme, plastiktop med foderluge, termometer, akvarienet, freebies fra Tropical

54 liter 60 x 30 x 30 cm
112 liter 80 x 35 x 40 cm
LED Expert-belysning 10W LED Expert-belysning 16W
Internt Claro filter (600 liter/time) Internt Claro filter (1000 liter/time)
Justerbart varmelegeme 50W Justerbart varmelegeme 100W
Få et GRATIS
BioBubble
med LED-lys

Akvaponisk havesystem
Fiskene i et akvaponisk dyrkningssystem spiller en vigtig rolle nedbryder fiskefoderet til små letopløselige partikler. Fisk for mindre vand og foder pr. kg. kød end både grise og køer. Derfor bæredygtigt protein, så fremover kan vi komme til at spise mange flere fisk end vi gør i dag. Tilføj kun vand, fisk og jeres plantefrø og se det hele gro.
20
Akvarienet Algemagnet
terrarie/ vækstklokke
(værdi kr. 349,-) ved køb over kr. 5000,-.
Brug koden "BIOBUBBLE" ved bestilling.
NYHED
OBS: begrænset oplag
Økosystemer
Evivo økosystem
Denne unikke plastikkugle indeholder et komplet biologisk afbalanceret akvatisk miniatureøkosystem. Mikroalgerne indeni genererer ilt og mad til indbyggerne - små rejer - gennem fotosyntesen. Rejerne bruger ilt og producerer kuldioxid ved at spise mikroalgerne. Mikroalgerne genbruger kuldioxid og omdanner det til mad og luft. De aerobe bakterier inde i økosystemet renser også rejernes affaldsprodukter. Levetiden for rejerne i dette økosystem er ca. 2 år eller længere.

Myrefarm
Udforsk myrernes verden: myrer graver tunnelsystemer og planter spirer i et økosystem. Verdens første og eneste myrehabitat testet under nul-tyngdekraftsforhold af NASA. Gelen i myrehabitat indeholder alt, hvad myrerne har brug for af mad og næringsstoffer,
Plantarium Plantesystem

Plantarium gør det sjovt at se 3 forskellige planter vokse sig større - både over og under overfladen. Den særlige gel kan udskiftes og indeholder alle de næringstoffer, der er nødvendige for en plante at overleve i det lille økosystem.
Plantarium, 3 små beholdere
Gel refill
Super Plantarium, 1 stor beholder


Gel refill
Start dit plantarium op på ny!
21
NYHED NYHED
NYHED
Bestrålede plantefrø
Majsfrø til udspaltning
Bestrålede raps- og radisefrø
Frø udsat for stråling, anvendes til at påvise virkningerne af varierende grader af stråling. Præparater af rodspidserne viser tydelige forstyrrelser af det normale mitotiske mønster. Somatiske ændringer anlagt ved bestråling er ofte tydelig kort tid efter spiring begynder.




Rapsblomst 12x

12x forstørret model af rapsblomst. Oplagt til at studere blomsters anatomi og den grundlæggende forståelse af blomstens opbygning.
Majsfrø til genetiske forsøg med klorofylmutanter. På kun 2 uger ser eleverne resultater i planternes dominante og recessive gener. Leveres i breve med 100 frø.
Grøn/albino 3:1 Høj/dværg og grøn/albino 9:3:3:1

LED vækstlys
Med en god LED lampe sikres det bedst mulige resultat og laveste strømforbrug. Perfekt LED grolampe til undervisning, hobbygartnere og professionelle, som ønsker kvalitets plantelys til en meget billig pris.


Grotelt
Samles nemt på få minutter. Lystæt ventilationshul. Kraftig topstang til ophængning af vækstlampe og diverse tilbehør. Vandtæt bundbakke sikrer, at eventuelt overskydende vand og skidt ikke løber ud af teltet. Ventilationshul med gitter til udluftning, samt hul til strømføring. 80 x 60 x 80 cm.
22
Radisefrø Rapsfrø
Bestråling
UV - perler
Perlerne skifter farve, når de udsættes for sollys (uv-stråling) og kan bruges igen og igen.
UV detektor (ikke ill.)
Lille smart detektor til aflæsning af mængden af stråling. Perlerne ændrer farve ift. intensiteten, så kraftig farve er lig med stærk stråling.
UV - filter (ikke ill.)
Sæt fremstillet i plast. Det ene absorberer UV og det andet gør ikke.

UV - lys, bærbar (ikke ill.)
Bærbar 4w langbølget UV-lys er praktisk til små, close-up demonstrationer. Før lyset over pengesedler og mineralske prøvereleverne vil især elske lysets effekt på Haribo's vingummi-ferskner!
GoDirect Radiation Monitor


Udforsk strålingsdata, mål radioaktivt forfald og overvåg radonstråling. Sensoren består af et Geiger-Muellerrør monteret på et lille, robust plastikhus og gør det muligt at spore alfa-, beta- og gammastråling. Brug monitoren i flere eksperimenter:
• Bestem halveringstiden for en isotop
• Undersøg strålingsafskærmning
• Opdag baggrundsstrålingskilder
Digital radondetektor



Meget brugervenlig radonmåler som er udviklet til måling af radonniveauet i eks. bygninger. Sæt batterier i og vent til apparatet har udført den automatiske kalibrering - så er du klar.
Geiger Pro
Forbindes direkte til din Android ™ eller iOS®-smartphone og registrerer miljø gamma- og røntgenstråling ved hjælp af en gratis downloadbar app. Let at medtage og kræver ingen batterier.

23
Mød SCOBY!
Kombucha-tesvampen 'SCOBY' er den oplagte undervisningsmakker til tværfaglige forløb i biologi, kemi, bioteknologi m.fl.

SCOBY, der står for “symbiotic culture of bacteria and yeast”, er en blanding af gærceller og gode bakterier i en cellulosemasse.
Lær f.eks. om:
• cellebiologi: overordnet opbygning af pro- og eucaryote celler og membranprocesser
• mikrobiologi: vækst og vækstfaktorer
• makromolekyler: overordnet opbygning og biologisk funktion af carbohydrater, lipider, proteiner og DNA
• enzymer: opbygning, funktion og faktorer, der påvirker enzymaktiviteten
• biokemiske processer: fotosyntese, respiration og gæring
• økologi: samspil mellem arter og mellem arter og deres omgivende miljø
SCOBY kombucha-starter
Minimumvægt 80-95 g inkl. startervæske.
GoDirect pH-sensor, trådløs


pH-sensoren er et vigtigt og alsidigt redskab til både laboratorie og udeaktiviteter.
Live-aflæsning og indsamling af data i realtid. pH-sensoren kan anvendes til forsøg med enzymer, hvor det er muligt at undersøge enzymaktiviteten ved varierende pH-værdier.
Oechslevægt, gærmåler
Flydevægt til at bestemme sukkerindhold i gærede væsker, som vin eller øl. Kan bruges til at fastslå, hvor langt i gæringsforløbet væsken er, og til at beregne alkoholprocenten.
Teststrips Glucose


Hurtig og effektiv indikator, til måling af glukosekoncentrationen i væsker. Pakke med 50 stk.

OPLAGT TIL TVÆRFAGLIGE FORLØB!
Cellerespiration og gæring, sæt
Sæt fokus på de fysiologiske forskelle mellem aerob cellulær respiration og gæring. Lær om ATP-produktion i glykolysen, citronsyrecyklus og elektrontransportkæden og sammenlign ATP-produktionen af både mælkesyre- og alkoholgæring. Inkl. materialer til 32 elever og vejledning (engelsk).

Enzymer - naturens katalysator
Lipase, 25 g
Hydrolyserer triacylglyceroler (fedtstoffer) i fedtsyrer og glycerol.


Pektinase, 100 mL
Enzymet nedbryder cellevægge og benyttes i juiceproduktion.
Pepsin, 25 g
Et vigtigt enzym i mavens fordøjelsessystem.
Laktase, 50 mL
Nedsætter indholdet af laktose i mælk.
Amyloglukosidase, 100 mL
AMG fjerner glukose fra flydende stivelse og producerer glukose.
Osteri, lav din egen ost
Alt det du skal bruge - undtagen mælken - er med i dette ostekit. Fremstil en række spændende oste: hytteost, camembert/brietype, blåskimmelost/castellotype, fetaost, havarti og danbotype, ricotta, myseost, rygeost, friskost og flødeost.
Inkl. forbrugsstoffer til ca. 20 ostninger á 8 liter mælk (forbrugsstoffer kan løbende tilkøbes).
Cellulase, 25 g
Cellulase er et enzym som spalter cellulose til glukose.


Katalase, 1 mL
Omdanner hydrogenperoxid til ilt og vand.
Osteløbe, 100 mL
Mikrobiel osteløbe.
Neutrase, 100 mL
Neutrase nedbryder proteiner til polypeptider eller peptider. Bruges f.eks. til at udvinde DNA fra løg.
Termamyl, 100 mL
NYHED
Madkemi

Der er lus i din spegepølse!
De fleste, der køber rød salami, ved godt, at pølsen er fyldt me E-numre og farvestof, men vidste du, at producenterne med fuldt overlæg tilsætter ekstrakt fra lus? Karmin er et kraftigt farvestof, der er et aluminiumsalt af karminsyre, som kan udvin fra skjoldlusene. Karmin anvendes blandt andet som farvestof i fødevarer under E-nummeret E120 - i undervisningen er den også oplagt til farvning af celler i vandpestblade eller kromosomfarvning.

Karmin
E120 Karmineddikesyre 1%
Dåse med 12,5 gram. 30 ml i pipetteflaske.
Æblepresse / Mosteri
Til vin, olivenolie og juiceproduktion - italiensk kvalitetsmærke! En star-presse model er en rigtig arbejdshest og derfor særlig anvendelig til institutionsbrug. Begge modeller kan også anvendes til hårdere frugter, som æbler og pærer.
Modellen rustfrit stål er særligt nem at rengøre (en særlig lukkemekanisme halverer kurven, når pulpen skal fjernes).
Materialevalget sikrer minimal vedligehold og alle metaldele er pulverlakeret.
Pressepose medfølger.
20 liter, lakeret bøg
20 liter, rustfrit stål

Pektinase, 100 ml

Enzymet nedbryder cellevægge og benyttes i juiceproduktion, for at optimere mængden af juice.
Smørkærne
1,6 l
Til hurtig smørfremstilling er denne franske kærne effektiv. Glasbeholderens form i kombination med rotationen omdanner hurtigt den syrnede fløde til herligt smør og rigtig kærnemælk.
Inddrag den i læren om laktose/ laktase.
Laktose, ren
Beholder med 50g mælkesukker-
Laktase, 50 ml Nedsætter indholdet af laktose i mælk.
26
NYHED NYHED NYHED
Nedarvning, DNA & genetik

Punnett Square Diagram
I forbindelse med arvelære bruges ofte det illustrative Punnett Diagram (krydsningsskema). I diagrammet placeres den ene forælders forskellige alleler (de der muligt kan være tilstede i individets gameter) i to celler ved siden af hinanden og den anden forælders alleler i to celler under hinanden, hvorefter de nemt "krydses".


De 56 magnetiske blomster i dette sæt viser 3 typer monohybrid krydsninger (fuldstændig dominans, u-fuldstændig dominans og co-dominans). Sættet inkluderer lærervejledning (engelsk).

Antropologisk kraniesæt
Nu får du en ekstra - nemlig 6 antropologiske kranier i vores populære sæt. Sættet består af Afarenis kranium, Africanus kraniumNY!, Habilis kranium, Erectus kranium, Neanderthalensis kranium og Steinheim kranium.

Hvert kranie måler cirka 25 cm. Håndmalede detaljer og realistiske teksturer gør disse replikaer til et fremragende værktøj til uddannelsesstudier. Sættet fremstilles nu af holdbar og vaskbar plastisolpolymer, og vil denne replika modstå lang tids brug og håndtering. Brug dem til øvelser med evolutionslære og kraniemåling.
Evolutionsduge
Arbejd med systematik, sortering og klassifikation på en aktiv måde.
Dyrenes Stamtræ
Måler 160 x 160 cm.
Evolution og klassifikation
Måler 120 x 120 cm.
Flere, bedre, billigere! Spar hele 55% OG få et ekstra kranie med!

27
DNA-model



Detaljeret DNA-model der viser: dobbeltspiralstrukturen i DNA, fosfat-deoxyribose
”rygraden”, og de fire baser: adenin (A), guanin (G), thymin (T) og cytosin (C). De forskellige molekyler og bindingerne imellem vises realistisk og tydeligt. Illustrerer på en god måde baseparringsreglerne. Måler 61 cm.
Magnetmodeller til ophæng
Magnetisk materiale til f.eks. whiteboard. Klip ud og arbejd med den interaktive model og udvikl derved modelleringskompetencer. Lav også stopmotion-film af processen.
Magnetmodel til translation

Lær om den del af proteinsyntesen, der foregår ved cellens ribosomer (translation). Forklar processen og forklar sammenhænge mellem mRNA, ribosom, tRNA og aminosyrer.
Lonza's FlashGel™
Elektroforesesystem
FlashGel gør det muligt at visualisere DNA imens det migrerer gennem gelen. I løbet af kun 4-8 minutter er DNA molekylerne separeret og klar til analyse. Metoden overflødiggør buffer, samt støbning og farvning af geler.

Lonza FlashGel starter kit
Inkl. kamera, dock, 9 pakker DNA kasette 1,2%, loading dye og DNA markør.
Lonza FlashGel kit


med kamera
Inkl. kamera, dock, 9 pakker DNA kasette 1,2%, loading dye og markør.
Magnetmodel til replikation og transkription
Vis replikationen og lav et dobbeltstrenget DNAmolekyle ved at sætte A-T og G-C over for hinanden. I transkriptionen dannes mRNA-strengen ved at sætte A-U, T-A og G-C over for hinanden. Illustrer de to processer og
Lonza FlashGel kassetter 1,2%
Sæt med 9 kassetter til hurtig gelelektroforese.
DNA 1,2%, 9 stk.
RNA 1,2%, 9 stk.
28
Disorder detectives, sæt
Eleverne går direkte ind i rollen som cytogenetikere, der arbejder på et hospital, mens de undersøger de diagnostiske muligheder i karyotype-undersøgelser. Alle materialer i sættet kan genbruges. Materialet er beregnet til en klasse med 30 elever, der arbejder i par.
• Forstå anatomien af humane kromosomer
• Diagnosticer patienter vha. kromosomundersøgelser




• Få talt om elevernes misforståelser i forbindelse med kromosomer
• Genbrug sættets unikke kromosomundersøgelsestavler og mærkater
Eldonkort, 30 tests
Komplet sæt til 30 tests inden for ABO og Rhesus systemerne. Med kort, lancetter, plastpinde og desinfektionsservietter. Dansk brugsanvisning indeholder lidt historie om blodgrupper, geografisk fordeling, samt forklaring til de enkelte grupper.
Humangenetisk smagstest, sæt
Undersøger den genetisk bestemte smagsrespons hos elever og deres familier i forhold til 3 forskellige kemikalier. Sættet indeholder rør med: PTC, natrium benzoate, thiourea og kontrol teststrimler. Hvert rør indeholder 100 teststrimler. Derudover inkluderes lærervejledning og stamtavle/ arbejdsark til kopiering (engelsk).

ABO-Rh blodtypebestemmelse med syntetisk blod
Blodtypebestemmelsesæt til 30 personer - et uundværligt redskab inden for biologiundervisningen. Med sættet tester eleverne 4 syntetiske blodprøver for at bestemme deres ABO og Rh blodtype. Den simulerede agglutination er meget realistisk.
Sættet indeholder ikke noget blod, blodprodukter eller andet af biologisk oprindelse, så der er ingen fare for overførsel af sygdomme.
Klar, parat med færdigstøbte petriskåle?
Er tiden knap, så anvend disse færdigstøbte petriskåle. Tag dem ud af køleskabet og de er klar til podning - slip for opvarmning, dosering, støbning mv. med risiko for kontaminering.
PCA i petriskåle
Til totalkim bestemmelse (plate count). Færdigstøbt i petriskåle Ø90 mm. Pakke med 20 stk., sterilt indpakket og klar til brug.
Maltekstrakt agar i petriskåle
Til dyrking af svampe - færdigstøbt i petriskåle Ø90 mm.
Pakke med 20 stk., sterilt indpakket og klar til brug.
Kødpepton i petriskåle
Til dyrking af bakterier - færdigstøbt i petriskåle Ø90 mm. Pakke med 10 stk., sterilt indpakket og klar til brug.
Eller støb-selv?
Kødpeptonagar, rulle
Til dyrkning af bakterier. Pølsen skæres i passende skiver med en steril kniv. Rækker til 18-25 petriskåle
Ø90 mm.
Kødpepton
Til dyrkning af bakterier. Opsmeltes i kogende vandbad eller mikroovn. Vejledning er påtrykt flasken. Steril, rækker til ca, 12 - 15 stk. petriskåle Ø90mm. 250 mL.
Maltekstraktagar
Til dyrkning af svampe. Opsmeltes i kogende vandbad eller mikroovn. Vejledning er påtrykt flasken. Rækker til 10-15 petriskåle Ø90 mm. 200 mL.



OBS: Al agar skal efter brug destrueres ved f.eks. afbrænding eller overhældning med klorin.

Dyppeplader

Uricult dyppeplader


Den ene side til colibakterier, den anden til almen bakteriepåvisning. Bakterieantallet aflæses direkte ved sammenligning med billedtavle. Kan anvendes i ferskvand, brakvand og saltvand - eller ved trykning imod overflader. Inkl. 10 prøverør, billedtavle og dansk vejledning.
Hygicult
Fordele:
• NordVal og AOAC valideret.
• Indeholder neutralisering af desinfektionsmidler.
• Hygicults knækled letter prøvetagning.
• Dansk brugsvejledning.
• Nem aflæsning ved hjælp af kontrolkort.
• Kræver ingen laboratoriefaciliteter udover et varmeskabdog kan resultater tit aflæses efter 1-2 døgn ved 37 °C.
• Standardiseret areal.
Hygicult Y & F
Beregnet til detektion af gær og skimmelsvampe/ svampesporer.
Mini-inkubator
Prisbillig bærbar digital inkubator - ideel til mikrobiologiske forsøg, såsom dyrkning af dyppeplader til mikrobiologisk analyse. Med den lave pris og kompakte størrelse er den perfekt til analyser på uddannelsesinstitutioner og små laboratorier. Et stort 20 liters kammer kan opbevare kolber og flasker op til 2 liter. Inkl. 2 justerbare/aftagelige hylder. Digital temperaturkontrol eliminerer behovet for eksterne termometre og gentagen "finjustering" af en analog kontrolknap. Blæser sikrer optimal temperaturfordeling. Temperatur +5 °C to +60 °C. 3 års garanti.
Hygicult TPC

Beregnet til monitorering af den generelle hygiejnestatus, da den fremmer vækst af alle typer af bakterier samt gær og skimmelsvampe.
Hygicult E
Beregnet til bestemmelse af enterobacteriaceae (colibakterier).

31
NYHED
Shaker med 20x20 platform
Anatomi
Mini skelet, monteret på hængende stander
Trods sin størrelse har dette skelet alle anatomiske strukturer og detaljer. Selve skelettet måler 80 cm (94 cm med ophæng).




Kraniet kan fjernes og adskilles i 3 dele. 3-delt aftageligt kranium (hovedskal, bund af kraniet, underkæbe).
• Aftagelige arme og ben

• Specielt monteret hofteled, til at demonstrere den naturlige rotation af hofterne
• Fleksibel ryg med bløde intervertebrale skiver. Lavet af slidstærkt, brudsikkert plast med fuld 3-års garanti.
Torso med hoved, 14 dele
Populær torso med aftagelige dele og organer: blotlagt hjerne (ikke udtagelig) og kraniehalvdel, øje med synsnerve, 2 lunger, hjerte i 2 halvdele, mavesæk, lever, tarmsystem med dæksel til blindtarmen, forreste halvdel af nyre, samt forreste halvdel af urinblæren. Mål: H87 x B38 x D25 cm.
Torso, 16 dele
Fin budgetvenlig torso i halv størrelse med detaljer af de anatomiske strukturer. Hjerne og indre organer kan tages ud og studeres nærmere. Venstre halvdel af torsoen viser muskulaturen og rygsøjlen er blotlagt.


Dobbeltsidet menneske, magnetisk
Dobbelt så meget læring med skelettet på den ene side og organer og muskelgrupper på den anden. I alt 17 magnetiske felter, 91 cm høj.
Skelet, gulvmodel i skum
Overdimensioneret puslespil hjælper elever med at lære navne, form og placering af alle de store knogler i menneskekroppen. Hvert af de 15 stykker er navngivet på bagsiden (på latin og engelsk). Skelettet måler 122 cm, når det er samlet.
32
Nyre
Kvalitetsmodel af nyren med binyre, blodkarrene og øvre del af urinlederen. Forreste halvdel af nyren er aftagelig, så nyrebark, nyremarv og blodkar kan ses. 20 vigtige betegnelser i den menneskelige nyre er inkluderet i vejledningen.
Leveres på fod.
Respirationsmodel, lunge
Demonstrer åndedræts-mekanismen med apparatet, der består af en glasklokke, der repræsenterer brystkassen, en gummimembran, repræsenterende mellemgulvet, og et Y-formet rør, der udgør det for luftrør og bronkier. To lungeformede balloner er forbundet til bronkierørerne. Lungerne fyldes og tømmes, når der arbejdes med gummimembranen (mellemgulvet). H18 cm.
Klassisk hjerte 2 dele, 2:1
2-delt hjerte model til en pris, hvor de fleste kan være med. Den forreste hjertevæg er aftagelige for at vise kamre og ventiler. Hjerte lidt mindre end 1:1, men med gode anatomiske detaljer.










Fordøjelsessystemet
Model i 3 dele af fordøjelsessystemet udført i naturlig størrelse, der viser systemet i grafisk relief. Tolvfingertarmen, blindtarmen og endetarmen er åben. Den tværgående tyktarm og fronten af maven er aftagelig for detaljeret undersøgelse af anatomien.
Skummodeller
Skummodel af hjerne, hjerte, øje eller tand, som hjælper eleverne til at forstå anatomiens kompleksitet. Modellerne deles i to med hhv. navnene på vigtige områder (på engelsk) og påtrykte numre på den anden. Engelsk vejledning medfølger.
Hjerte
Tand

Øje, tværsnit Hjerne

33
UDGÅR!
BEGRÆNSET LAGER!
UDGÅR
dugen, så anvisningerne kan følges i forbindelse med undersøgelsen.Efter endt undersøgelse rengøres dugen med en mild sæbeopløsning. Når dugen er tør, kan den lægges væk og er klar til næste gang, der skal dissekeres et hjerte.
Hjerte 3D
Model med hjertekamre, hovedpulsåre, vener og lunger, som med en håndpumpe demonstrerer blodgennemstrømningen i hjerte og lunge. Ingen oprydning da væsken er indkapslet.
Lunge
Realistisk skildring af menneskets lunge med åben dissektion. Der er således mulighed for at iagttage lungearterierne, vener og luftveje. Lungehinden og lymfeknuder er ligeledes repræsenteret. Monteret på aftagelig plade. Måler 23 cm i højden.
Type 2 Diabetes model




En meget illustrativ og enkel model i 8 dele, der viser organforandringer ved Type 2 Diabetes.

34
Øre 5x forstørret, 3 dele
Budgetvenlig model, der viser det indre øre med alle de anatomiske dele.

Synsopfattelsen, klassesæt
Undersøg flere af de fysiologiske processer, der er involveret i menneskets synsopfattelse. Med udstyret kan eleverne undersøge synets skarphed, dybdeperception, farvesyn, bygningsfejl, positive og negative efterbilleder, optiske illusioner, m.m. Inkl. materialer til ca. 30 elever, der arbejder i små grupper.



De 5 sanser, byggesæt
Lær om kroppens sanser og sansefysiologi vha. et byggesæt med 3-D modeller af de 5 sanser. Samles med lim og males (lim og maling medfølger ikke).



Øje 3x, 6 dele
3 gange forstørret øje i øjehulen. Den øvre del af øjeæblet kan fjernes og deles i 6 dele der viser anatomiske detaljer. Modellen viser de 6 muskler, der styrer øjeæblet - to af dem kan fjernes for at demonstrere øjets bevægelsesapparat.



Hørelsen, klassesæt
Lav ti stationer, hvor eleverne undersøger egen hørelse og lærer om fysiologi og fysik bag lyd. Lav forsøg med: retningsbestemmelse, knogleledning og høretest. Viser sammenhængen mellem: lydbølger, tonehøjde og lydstyrke, om ørets opbygning, hvordan enkelte dele bidrager til hørelsen, og hvorfor høje lyde giver nedsat hørelse. Inkl.materialer til 30 elever i grupper af 3 (engelsk vejledning).
Øje i øjenhulen 3x,
7 dele
Stor model der viser synsnervens position i knoglens kredsløb. Øjeæblet kan tages ud og adskilles i:
• begge halvdele af senehinden med hornhinden og øjets muskelvedhæftninger
• begge halvdele af årehinden med iris og nethinde

• øjets linse
• glasøje
35
Kondition, muskler og helbred
Lommespirometer


Bruges til måling af lungernes vitalkapacitet. Spirometeret måler den gennemstrømmende luft, som aflæses på en skala inddelt fra 1000 til 7000 ccm. Spirometeret er kun 15 cm højt. 50 mundstykker medfølger.
Dynamometer

Smedley’s model til måling af håndens muskelkraft og musklernes afmatning. Måleskala fra 0 til 100 kg.
Blodtryks/pulsmåler
Mundstykker, 50 stk.
Promillebriller
Batteridrevet model med hukommelse til 90 målinger og angivelse af dato og klokkeslæt. Ved tryk på Start pumpes apparatet automatisk op, hvorefter luften lukkes ud. Målingen viser systolisk /diastolisk tryk og pulsfrekvens.
Populære promillebriller fra Drunk Buster til simulering af nedsat reaktions- og koordineringsevne, dobbeltsyn og forvirring. Designet som skibriller, der sidder stabilt ved bevægelse.
Vælg mellem 5 forskellige styrker:
Ecstasy/LSD brille




36
0-4-0,6 - 0,6-0,8 - 0,8-1,5 - 1,5-2,5 - 2,6-3,5
Cannabis/hashbrille
Tunturi E80 Ergometercykel


Med Turi E80 Endurance motionscykel kan du træne som en professionel. Cyklen tilbyder dig helt op til 43 forskellige træningsprogrammer indbygget i computeren. Den er også kompatibel med træningsapps (eks. Kinomaps, Tunturi Routes) for mange flere ruter og programmer. Motionscyklen kan bruges af langt de fleste og er perfekt til genoptræning, da den har en meget lav indstigning foran. Computerdata med:
• hastighed
• kalorier
• puls
• distance
• træningstid
• programmer

Kettler Tour 400 Ergometercykel

Den stabile TOUR 400 garanterer begyndere moderne, effektiv træning med absolut glathed og maksimal komfort. Enkle justeringsmuligheder for sadel og styr sikrer en behagelig pasform, selv ved lange sessioner. Inkl. 10 træningsprogrammer og computerdata med:
• hastighed
• kalorier
• puls
• omdrejningstal
• distance
• træningstid
• watt
Ergometerskive
Til pædagogisk anskuelse af beregning af konditionstal.


Douglassæk 100 L, m. tilbehør
En af de mest anvendte metoder til bestemmelse af den maksimale iltoptagelse er Douglas-sæk-metoden. Det er ud fra denne metode muligt at bestemme den maksimale iltoptagelse med stor nøjagtighed.
Sækken anvendes til opsamling af ekspirationsluften med henblik på undersøgelse af respiration, stofskifte og minutvolumen. Komplet med slange (2 m), mundstykke, næseklemme, ensretterventil og omskifter.

37
NYHED NYHED
Geografi og miljø

Hvad I ønsker, skal I få!
I samarbejde med danske gymnasielærere har vi udviklet en række spændende øvelser til undervisning i diverse geologiske kerneområder. Stensamlingerne kommer med komplette vejledninger tilpasset de danske grundskoler og studier.


Det geologiske kredsløb
Æske med 11 tyndslib, der kan bruges separat eller sammen med bestemmelsesdugen
"Det Geologiske Kredsløb".
Indeholder: basalt, granit, gabbro, gnejs, kvarts, sandsten, biogen kalksten, flint, syenit porfyr, carbosilikat skifer og konglomerat.

Oliens dannelse
Praktisk æske med 3 tyndslib; skifer, sandsten og biogen kalksten til undervisning i dannelsen af olie/naturgas, samt lagring af CO2 i undergrunden.
Smartphoneadapter til mikroskop


Universal adapter, der kan anvendes alle smartphones til bino- og monukular mikroskoper. Nemt og enkelt uden værktøj eller software.

39
NYHED
NYHED
Klassiske og moderne globusser

Tegneglobus, blank
Hvid globus fra Nova Rico med konturer af kontinenter, overordnede landegrænser og større floder. Tegn havstrømme, quiz hinanden om landenavne og meget mere!



Inkl. 4 "dry wipe" tuscher.
Stor globus på hjul
Flot og stor kvalitetsglobus på metalstativ med hjul - perfekt til faglokalet. Dobbeltfunktion med fysisk/politisk kort, når den er slukket/oplyst. Ø50 cm, 103 cm høj.

Børneglobus
Med dansk tekst, plastfod, lys og flotte illustrationer af dyr og vartegn! Ø30 cm.


40
Pusleglobus
Det er aldrig for tidligt at lære om geografi - og aldrig det været nemmere eller sjovere! Hvert kontinent er flytbart, men passer kun et sted. Kontinenterne er flot illustreret med sjove dyr og berømte vartegn.




Globus med relief


Flot globus med lys og 3D-relief over landområderne, så bjergkæderne fremhæves. Når globussen er tændt er den politisk og i slukket tilstand er den fysisk. Måler 30 cm, monteret på sort plastfod og med engelsk tekst.
Klassiske globusser med dansk tekst
De traditionelle globusser i deluxe eller basismodel. Begge har en dobbeltfunktion, der viser den fysiske information, når den er slukket, hvor ørken, skov og hav fremtræder i klare farver. Når lyset er tændt, gennemlyses et underliggende lag, der viser tydelige politiske inddelinger og landegrænser fremtræder tydeligere. Diameter 30 cm.
Globus deluxe med bøgetræsfod og meridian i messing
Basisglobus med sort plastfod (ikke illustreret)
41
Danmarkskort på plastdug
Flot og detaljeret danmarkskort printet på en kraftig plastdug, som den kendes fra vore bestemmelsesduge. Dugen holder til at man går eller sidder på den, og kan derfor lægges ud på gulvet eller tages med på ekskursion. Der kan også tegnes på dugen med farvekridt og dugen tørres nemt ren med en fugtig klud. Ofte kan det være hensigtsmæssigt at have kortet fremme i undervisningslokalet over en længere periodehæng derfor blot dugen op med magneter på whiteboard eller opslagstavle. Måler 137 x 155 cm.

Meterhjul
Håndtaget kan justeres i fire forskellige indstillinger og passer til både børn og voksne. Hjulet er belagt med gummi og kan anvendes inde og ude



Digital kortmåler
Handy lille elektroniske måler informerer om afstand og forventet ankomsttidspunkt mellem to punkter meget præcist. Indtast kun kortets målestok og du vil med det samme kunne måle afstanden på kortet. Robust og vejrbestandig.
Kortmåler


"Kør ruten" på landkortet og aflæs afstanden i kilometer direkte på én af 8 skalaer med forskellige målestokforhold. Kan måle på følgende kort:
1:500.000, 1:300.000, 1:200.000, 1:150.000, 1:100.000, 1:75.000, 1:50.000, 1:25.000.
Teodolit
Meget solid med højdeindstillelige teleskopben. Højdeindikator med bevægelig vandret og lodret indstilling med tydelig afmærkning i grader.

42
Stensamlinger, 5 forskellige
Vælg mellem 5 fantastiske samlinger - eller køb dem alle og spar penge! Vælg mellem: metamorfe, sedimentære eller magmatiske bjergarter, fossiler eller mineraler.
Stensamling: magmatiske stenarter
Udarbejdet til øvelsesvejledningen "Navngivning af Magmatiske Stenarter".
Indeholder:

Granodiorit
Dolerit
Basalt
Gabbro
Pink Granit
Rhyolit
Andesit
Diorit
Mineral testkit




Test hårdheden med Moh's hårdhedsskala med glaspladen, sømmet og kobber kvadratet. Undersøg stregfarven med stregpladen og se hvorvidt mineralet har stærke, mellem eller svage magnetiske egenskaber. Test opbrusningen med dråbeflasken og saltsyre (ikke inkl.!) og brug foldeluppen til nærstudier.

Stensamling: pladetektonik og densitet
Udarbejdet til øvelses-vejledningen "Pladetektonik og Densiteten af karakteristiske bjergarter".
Indhold:



Granit
Basalt
Peridotit
Eklogit
43
Grundvandsmodel

Betagende grundvandsmodel beregnet til at give en visuel demonstration af basale grundvandsprincipper eller i forbindelse med hydrogeologiske forsøg.
Begreber som porøsitet og permeabilitet, grundvandsstrømmen, karakteristika for akvatiske stoffer, dannelse af en kegle af depression, brøndkontaminering, overfladeudvaskning af forurenende stoffer og mere, bringes til live. Tilføj farvestof til at vise grundvandsstrømningslinjer, virkningerne af pumpning af brønde og virkningen af kontaminering på ferskvandsforsyninger.
Inkl. danske øvelsesvejledninger tilpasset til grundskolen eller STX/HTX med;
• den teoretiske baggrund
• formålet med øvelsen
• vejledning i udførsel af øvelsen
• opsamlende arbejdsspørgsmål

• lærerdel, som angiver tidsforbrug og forberedelser
• oversigt over de FFM/dele af bekendtgørelsen
øvelsen opfylder
Grundvandsmodel Sediment-refill




Sten og mineraler





Vælg mellem hæmatit, kobber, magnetit, basalt eller bauxit. Pakker med 8 eller 10 stk.
Pürckhauer jordprøveoptager
Pürckhauer-model, der består af rør i hærdet titanium og stål.


Vælg mellem:
Let jord, stenet jord, tung jord
Sigtesæt
Sigtesæt til bestemmelse af kornstørrelsen. Dette sæt er tilstrækkeligt til klassificere kornstørrelse og jordtyper, som f.eks. ler, sand, silt og grus. Kanterne er lavet i plastik og har en diameter på 170 mm. Sigtebundene er lavet af messing eller rustfrit stål.
3,35 / 1,7 / 0,25 / 0,071 mm.

Varenr.: 301459
Pris: 798,00 kr.
3,35 / 1,7 / 0,43 / 0,25 / 0,125 / 0,071 mm.
44
Bølgekar
Bølgekarret viser, hvordan forskellige kombinationer af kystbeskyttelse og bølger/tidevand har betydning for overskyl og oversvømmelse. Overskyl måles præcist for hvert af medfølgende kystværn og forhold, og bruges som vejledning til de forskellige kystbeskyttelsesmetoder:
• alm. strand ved stormflod
• vertikal og skrå højvandsmur
• skråningsbeskyttelse (trappe og skrånende)
• bølgebryder
• undervands for-forkastning

Inddrag beskyttelsesmetodernes virkning og hold dem op mod de økonomiske ressourcer, som de hver især kræver - både kort- og langsigtet. Tag tværfaglige snakke om metodernes miljøpåvirkning og risikoen for at spolere naturværdier, æstetik og socioøkonomiske/tekniskøkonomiske synergieffekter.
Endelig kan I vurdere effekten af alternative designs - eks. kystdræn, sandfodring, plantesikring m.fl.




Bølgekarret indeholder modeller af de mest benyttede kystværn, og giver mulighed for at eksperimentere med hver enkelt, lave kombinationer og måle overskyl i måleglas ved hvert scenarie:
• hvilke kystværn er de mest effektive?
• hvilke kystværn har de største omkostninger - inddrag betragninger om økonomi, naturbevarelse og æstetik
• tal om bølger, havstrømme og hvilke faktorer, der spiller ind på bølgernes størrelse BESTIL DEMONSTRATION
45
PÅ
- OG SE FILM
WEBSHOPPEN!
iSandBOX


- den interaktive sandkasse!
• Få mediedidaktik, innovation og modellering ind i undervisningen
• Brug iSandBOX i naturfagene, sprog- og kulturfag, sanseterapi m.fl.
• Styrk skolens teknologiske profil
'One tool to rule them all'
NU INKL. ALLE 29 SCENARIER
- så meget læring i ét læringsværktøj!
Dette revolutionerende læringsværktøj er taget i brug i gymnasier, grundskoler og skoletjenester landet over, hvor undervisere melder tilbage om spændende læringsforløb i geografi og biologi indenfor bl.a.:


✅ Hotspotvulkaner
✅ Caldera
✅ Koralrev & atoller
✅ Erosion
✅ Vandets kredsløb
✅ Topografisk opland
✅ Regnvejrstyper
✅ Klimaforandringer
✅ Fluvialmorfologi
✅ Istidslandskaber
✅ Høje vs. lave gletchere
✅ Artsdannelse
✅ Klimazoner
✅ Plantebælter
✅ Kartografi
✅ Planeter
✅ og meget mere!
46
Højdekort
Form jeres lokalområde i sand! Scenariet har justerbar målestok og konturlinjer gør det nemt at lave en præcis gengivelse af et terræn med vandveje, bakkedrag og lavland.


Bestil en fremvisning!
Bestil en 'playdate' i sandkassen, hvor vi kan demonstrere og I selv kan prøve iSandBOX' 29 spændende scenarier.
Vi arrangerer gerne demonstrationer på forskellige lokationer rundt om i landet eller laver fremvisninger via Zoom eller lign.
Kontakt os på tlf. 4913 9333 eller info@scandidact.dk.




Vandets kredsløb
Skip tavleundervisning og demonstrer vandets kredsløb, vejrsystemer og de forskellige regnvejrstyper - det er rent magi, når I lader det regne i sandkassen med jeres egne hænder!
47
NYHED
Vulkan model (stratovulkan)
Lær om vulkaner og deres funktioner, årsager, samt påvirkning af miljø og mennesker. Modellen illustrerer de forskellige skorper, lavarør og dannelse af vulkanen, samt tværsnit gennem vulkanen.
Mål: 42 cm lang x 42 cm bred, 21 cm høj



Stenenes kredsløb
Undersøg vulkanske, sedimentære og metamorfe bjergarter, der nedbrydes og gendannes i et evigt geologisk kredsløb.

Pladetektonisk model



Flot model, der viser dannelsen af ny havbund ved en undersøisk vulkan. Modellen viser eks. kontinentalsokkel, forkastninger, foldebjerge og dybgravsdannelse.
Kæmpe spiralfjeder
Lang bølgespiral til at demonstrere og observere jordskælvsbølger. Fjederen måler 20 cm komprimeret og kan strækkes op til 20 meter. Opbevares på det medfølgende træstativ, hvilket forlænger levetiden betragteligt.
Premium seismograf
Seismograf Model til demonstration af seismiske forstyrrelser i faglokalet. Kan bruges til både matematiske og geologiske koncepter. Træk langsomt i papiret og start "optagelsen" af bevægelser i nærheden af modellen - eks. ved hop på gulvet eller bank i bordet.
Forkastninger og brud, 5 dele
Vis forkastninger og folder i jordskorpen, effekten af tektonisk stress m.m. Inkl. identifikationsnøgle.
48
Landskabstyper 8 dele
Otte separate modeller danner en 3D-model med bjerge, søer, floder, ørkener, gletsjere, kystlinjer, kløfter og kulturelle punkter. Nu udført i håndmalet træ med filtunderside.



Vandets kredsløb

Magnetisk planche til undervisning i vandets kredsløb på eks. magnetisk tavle eller whiteboard. Ved tilkøb af magnetiske fokuspunkter (15 stk.) har I alt, hvad I behøver for en lærerig lektion om miljø og klimaforandringer, grundvand, spildevand, nedbør og mange andre naturfaglige kernebegreber.

Planche, mål: 127 x 90 cm
Magnetiske fokuspunkter, 15 stk.
Havbund, simulationssæt
Lær om havbunden, havstrømme og pladetektonik. Modellen kan bruges, som den er eller nedsænkes i et fyldt akvarie (tilkøb) for en ekstra god læringsoplevelse. Under vand kan modellen f.eks. simulere havstrømme med lidt frugtfarve og lave undersøiske vulkanudbrud ved brug af en luftpumpe (ikke inkl.). Kar
til havbunden
Ny forbedret kvalitet - samme lave pris!
Nye vinde blæser...
Energiboksen



Boks fyldt med vedvarende energi, der giver en komplet forståelse af, hvordan brændselscelleteknologi interagerer med vedvarende energikilder for at skabe et helt bæredygtigt elnet. Solenergi, vindenergi, kinetisk energi fra et håndsving og en demonstration af en superkondensators utrolige lagringspotentiale. PEM-brændselscelle, saltvandsbrændselscellen og en direkte ethanolbrændselscelle kan sammenlignes. Du skal bruge en brintkilde som Hydrofill Pro for at oplade den medfølgende Hydrostik Pro-patron med brint. Inkl. vejledninger og aktivitetsguide (engelsk) til kemi, fysik og naturfag og praktisk opbevaringskasse med låg og hjul.
Kernestof i kemi: biobrændsel, elektrolyse, elektrokemi, ethanol reaktion, organisk kemi, pH, hydrogengenerering, reaktionshastigheder, halvledere, opløsningskoncentration
Kernestof i fysik: vinkelhastighed, kondensatorer, elektrisk ladning, lys, varme, klassisk mekanik, effektivitet, energi, elkraft, Ohm's Lov, elektricitet, rotationsmekanik, termisk energi, paralelle kredsløb, seriekredsløb


Kernestof i biologi/geografi: vedvarende energi, klimaforandringer, menneskets påvirkning
Vindmølle med dioder
Gør studerende i stand til at opfinde deres egne applikationer med ren energi ved hjælp af en lille elmotor, der drives af en brændselscelle. Brint produceres gennem vandelektrolyse af en reversibel PEM-brændselscelle, der selv drives af en vindmølle med profilerede vinger baseret på NASA-teknologi
• Udforsk støkiometri, reaktionshastigheder og andre kemiske begreber ved at generere brint fra vindkraft
• Brug vinkelhastighed, trækkraft og andre fysiske koncepter til at designe og bygge en effektiv vindmølle
Kernestof i kemi: elektrolyse, energi, hydrogengenerering, reaktionshastigheder, støkiometri
Kernestof i fysik: vinkelhastighed, klassisk mekanik, effektivitet, energi, elkraft, Ohm's Lov, elektricitet, rotationsmekanik
Kernestof i naturfag: vedvarende energi
50
DIY Brændselscelle
Med DIY Brændselscelle sæt får du alt, hvad du behøver for at opdele vand og bruge dets brint til at generere elektricitet.Hvad den elektricitet bruges til, er op til dig. Brug vores medfølgende aktivitetsvejledning, eller kom med dine egne ideer. Hvordan vil DU forme fremtidens energi?
Den medfølgende lærervejledning indeholder materiale om miljø og klimaforandring, brændselsceller og aktivitetsguide.
Kernestof i kemi: elektrolyse, energi, hydrogengenerering, reaktionshastigheder, reaktionsudbytte, redoxreaktion
Kernestof i fysik: klassisk mekanik, effektivitet, elektriske kredsløb, energi, Ohm's Lov, elkraft
Kernestof i biologi/geografi: klimaforandringer, vedvarende energi, menneskets påvirkning
Energimonitor og datalogger

Ved brug af energimonitoren bliver volt, strøm, effekt, joule, modstand og omdrejningshastighed alle tilgængelige ved tryk på en knap - vises enten på skærmen eller som grafiske data på din pc. Energimonitoren bringer laboratorie- og felteksperimenter tilbage i klasseværelset, hvilket gør det til det ideelle værktøj til at supplere:
• Vind til Hydrogen sæt (varenr. FCJJ56)
• Vedvarende Energi (varenr. 421751)


• Vindmølle med dioder (varenr. 500545)
Vindturbine

Vindmøllevidenskabssæt med vertikal akse er det mest omfattende uddannelsesprodukt for vindenergi på markedet i dag. Det giver eleverne mulighed for at udforske simpelt vindmølledesign ved at tilbyde 3 forskellige kombinationer af knivpositioner. Eleverne kan også producere deres eget design.
• 3 forskellige knivkonfigurationer
• Mere end 25 timers aktiviteter, der dækker fysik og jord- / miljøvidenskab
• Oplev banebrydende vindmølleteknologi
Kernestof i fysik: vinkelhastighed, klassisk mekanik, effektivitet, energi, Ohm's Lov, elektricitet, rotationsmekanik Kernestof i naturfag: vedvarende energi
51
DIY Brændselscelle sæt
DIY Brændselscelle klassesæt
Vandstrømsbord, deluxe

Lav den mest detaljerede og grundige demonstration af sedimentering og landskabsdannelse med vand. Størrelsen alene gør det muligt at lave store, flotte demonstrationer. Demonstrer dannelsen og forandringer af kystlinjen. Lad regnen skabe landskabet, følg vandløbet og sedimenteringen, aftegn topografiske konturer m.m.
- Hvordan udvikler et vandløb sig?
- Hvordan foregår erosion og aflejringer?
- Hvad er et dige?

Sættet inkluderer:
• Sort vandløbskar: 170 x 66 x 16 cm

• To individuelle vandløb, der flyder fra kontrolpanelet
• Bord støbt i kraftigt, brudsikkert plast på hjul
• Gitter til aftegning af konturer
• "Regnsky"
• Sand
Topografisk model i 3D


Designet som et udsnit af et naturligt landskab med højdekurver og farveforskelle. Landskabet har både bakker, dale, højdedrag, kildeudsping, snoede vandløb m.m. Landskabet kan skilles ad og bygges op. Inkl. identifikationskort, som hjælper til at lære at læse og forstå modellen og dens opbygning. Modellen måler 50 cm.

Vandstrømsmodel
Demonstrer et vandløbs tilblivelse med erosion og aflejringer eller brug karret som tsunami-kar. Karret måler 122 x 37 x 6,5 cm.
Sedimentrør
Ryst røret og observer den gradvise sedimentering, deponering og lagdeling, som den forekommer i floder, vandløb, sumpe, søer og hav.
Kvartssand

Cirkulationspumpe

52
Materialesamling

Lær om forskellige materialer og deres egenskaber i temaer om produktion, miljø, affald og ressourcer. Sættet består af 20 prøver på jern, rustfrit stål, aluminium, træ, PE, messing, gummi, kobber, uld, nylon, kork, bly, zink, kulstof, glas, PVC, bomuld, pap, akryl og nikkel.



Vejrfænomener
Eksperimenter med statisk elektricitet og skab skyer i din håndflade. Opbyg en vandcyklusmodel, se luftstrømme, der producerer vind og studer effekten af syreregn og gennem disse forsøg skabe forståelse for vejrfænomeners opståen.
Vandrensningskit

Lær eleverne, hvordan man nemt og enkelt kan filtrere urent vand til rent ved hjælp af naturlige materialer. Sættet viser nemt, hvorfor mange hurtigt løbende vandløb indeholder rent vand, samt den videnskabelige måde at udvinde salt fra havvand.
Bræt- og kortspil - hygge med fagligt indhold
Vores udvalg af danskproducerede brætspil kan justeres i spilletid og er derfor perfekte til juleafslutning, vikartimer m.m.
Global Cooling

Spil om miljø, grøn disponering og bæredygtighed.

Phaunie-kort

3-i-1 kortspil for de mindste; Vendespil, Skraldeper og det sjove Fire på Phaunie.
Skraldeludo brætspil
Om genbrug og affaldssortering - slå dine modstandere hjem, så det bliver svært for dem at udføre deres opgaver.

53
NY ØVELSESVEJLEDNING TIL GRUNDSKOLE OG STX
NYHED
Fysik

Elektronik
Snap Circuits® gør det legende let at lære om elektronik - uden brug af værktøj! Sættene kan kombineres og med hvert sæt er der nok til mange timers læring og sjov.



Snap Circuits®, Begynder
Farverige billeder i manualen baner vej, så de yngste kan bygge over 20 spændende projekter med lyd, lys og bevægelse! Fra 5+.
Snap Circuits®, Lær at kode
Lær om basal kodning. Download Snap Circuits® app'en og brug din smartphone/tablet og Snap Circuits® kodningsmodul til at styre dine projekter med lyd, lys og bevægelige dele. Fra 8+.

Snap Circuits®, Mit Hjem


Dit hjem, din strøm - lær hvordan det virker! Lav forskellige projekter med sikkerhedssystemer, lysdæmper, automatisering, loftventilator, elektroniske husholdningsapparater, bevægelsesdetektor m.m. Fra 8+.
Snap Circuits®, Grøn Energi
Lær om moderne vedvarende energiformer - udforsk elbiler, vindmøller og dynamo. Perfekt til den lille ingeniør! Fra 8+.

Snap Circuits®, sæt til 500 eksperimenter
Tag el-læren til 'the next level' og lav spændende projekter med eks. FM radio, digital stemmeoptager, tyverialarm, dørklokke m.m. Med analog meter, transformer, relæ, LED-display og meget mere. Fra 8+.

NYHED NYHED NYHED NYHED NYHED
Sjov med magneter
Magnetsæt nr. 1, kuffert
Alt hvad hjertet begærer af magneter og kompasser til at undersøge kernebegreberne indenfor magnetisme. Eksperimentér med syd- og nordpol, ferreomagnetiske kæder og hvirvelstrømme eller magnetfelters linjer vha. jernfilspåner. Pakket i luksuriøs metalkuffert.
Magnetsæt nr. 2, kuffert
Magnetsæt nr. 2 er tænkt, som supplement til Magnetsæt nr. 1 og tilføjer læring om forskellene på diamagnetiske, paramagnetiske og ferromagnetiske substanser, magnetfelter og induceret strøm.

Bemærk: Magnetsæt nr. 1 er nødvendig til visse aktiviteter i den medfølgende aktivitetsguide (engelsk).
Magnetit


Pakker med 10 stykker, ca. 3 x 4 cm.

Stangmagneter


Klassesæt med 20 stangmagneter leveret i praktisk opbevaringsæske.
Deluxe magnetsæt
Flot udvalg af magneter og materialer pakket i en robust opbevaringsæske.
Magnetfeltplader, 4 stk



Plader med små magnetstave til demonstration af magnetfeltlinjer, uden de klassiske løse jernfilspåner. Stil f.eks. pladerne vinkelret på hinanden og demonstrer magnetfeltlinjerne i 3D.

Magnetfeltmodeller
Anvend med kompasser eller jernfilspåner for at vise feltlinjerne. Vælg mellem_
Lodret tråd
Vertikale vindinger
14 vindinger
56
Solens, Jordens og månens kredsløb
Demonstrerer dagslys, nat, årstider og månefaser. En 12 V pære i solen hjælper til at demonstrere sollys på månen og jorden. Basen viser årets måneder og sæsoner.

33 cm høj. Bruger to AA-batterier (medfølger ikke).
Drejeligt stjernekort

Det velkendte redskab til at orientere sig i stjernevrimlen. Kortet kan bruges året rundt: Den øverste plastskive drejes, således at dato og klokkeslet står ud for hinanden, og viser den aktuelle stjernehimmel.
Globus med stjernehimlens
konstellationer
Flot stjerneglobus på fod med 8cm jordklode i midten. Viser mælkevejen, samt de store stjerner og stjernebilleder. Ø30 cm.
Magnetisk solsystem

Praktisk som introduktion til solsystemet. Sættet består af 12 magnetiske dele.

Plakat med stjernehimlens
konstellationer

Flot stjernekort med den nordlige stjernehimmel til faglokalet. Konstellationerne angives på dansk, engelsk og latin.


Astronomi
NYHED
Kemi

Kemikalier
Agarpulver, 175 g
Hex-1-en, 500 mL
Natriumhydroxid, granulat, 200 g
Ammonium jern(III)nitrat, 100 g
Hydrogenperoxid, 30 %, 2.5 L
Natriumiodid, ren, 100 g
Bariumnitrat til analyse, 250 g
Jernpulver, rent, 200 g
Natriumthiosulfat, 1 kg
Calciumchlorid, 0,01 M
Kaliumbromid, ren, 100 g
Octanol-1, ren, 100 mL
Calciumoxid, pulver, 500 g
Kaliumferricyanid, 250 g
Pepton, ren, 100 g
Cetylalkohol, 100 g
Kobber(II)sulfat, ren, 200 g
PH 4,0 Kalibreringsopl. PH-Analyse
Eddikesyre, min 99 %, 1 L
Magnesiastænger, 25 stk
PH 7,0 Kalibreringsopl. PH-Analyse
Ethanol, 99,9 %, udenatureret, 1 L
Natriumacetat, vandfri, 500 g
Pimpsten, kogesten, 200 g
Fosfat, standardopløsning 500 mL
Natriumchlorid, fint, 200 g
Svovlsyre, koncentreret >95%, 1 L

59
HER ER ET LILLE UDSNIT! ( ...og der er mange flere på vej! )
KØB JERES KEMIKALIER HOS SCANDIDACT -
Molekylebyggesæt magnetisk
Arbejd med et molekylebyggesæt, hvor alle kan være med. Elementerne klippes ud og materialet er magnetisk, så det f.eks. kan anvendes på et whiteboard.
Det Periodiske System - alm. eller magnetisk
Det periodiske system i en magnetisk udgave, så det f.eks. kan anvendes på et whiteboard. Alternativt fås samme model i en praktisk plastdug i samme holdbare kvalitet, som I kender den fra de populære bestemmelsesduge. Dugen kan holde til at man går eller sidder på den, og den kan derfor med fordel lægges ud på gulvet. Man kan også hænge den op på en opslagstavle.



Plastdug Magnetisk dug
Glasvarer - fås også som 1 stk.!
Bægerglas, lav form, 10 stk.
Bægerglas, høj form, 10 stk.
Erlenmeyer kolber, 10 stk.


Treben
Trefod i stål med zinkbelagt overflade.
Magnetpind

Vælg mellem 2, 3, 4, 5, 6 og
7 cm. Syre- og varmefast.
Dobbeltmuffe
Stativmuffe, der kan bruges både horisontalt og vertikalt.
Magnethenter
Teflonovertrukket med stærk magnet. 30 cm.

50 ml 100 ml 250 ml 600 ml 1000 ml SE DET STORE UDVALG PÅ SCANDIDACT.DK /NATURFAG
25 ml
100
250
600
100
250
500
50 ml
ml
ml
ml
ml.
ml.
ml.
Ledningsevnemåler
Robust og pålidelig lommeformat tester med hurtige og præcise aflæsninger. Er udstyret med en amperometrisk grafitelektrode, der giver en bedre repeterbarhed, da de ikke oxiderer. Kalibreres med medfølgende værktøj.
pH, ledningsevne og temperatur
GOD PRÆCISION TIL SKOLEBRUG!
Varmeskab "Memmert"
Model UN30. Regulering af temperatur fra +30o til +220o C. Temperatursikring, tænd-slukur med digital aflæsning i 1/1o Leveres med 1 stk. trådhylde i rustfrit stål.
OBS: ALTID PÅ LAGER!
Mikropipette, LLG, var. volumen
De tyskproducerede mikropipetter giver med deres afrundede form og soft grip-gummibelægning en behagelig og sikker håndtering.

• Ergonomisk udført for behagelig håndtering
• Maksimal præcision og nøjagtighed
• Farvekodede
• Nem og hurtig kalibrering og vedligeholdelse
• Autoklaverbare
Vælg mellem: 0,1 - 2,5µl, 0,5 - 10µl, 2 - 20µl, 10 - 100µl, 20 - 200µl, 100 - 1000µl, 500 - 1000µl




Vandbad 6 huller

Digitalt vandbad med 6 huller med låg. Ikkefuget vandtank udført i korrosionsbestandigt rustfrit stål. Den ydre skal er fremstillet med en slidstærk pulverlakering, der er kemikalieresistent.
Karret måler 500 x 300 x 150 mm.
Kombinationstester, der er konstrueret til meget nøjagtig og hurtig, pålidelig måling af pH, EC/TDS og temperatur. STOR VÆRDI FOR PENGENE!
61
Lovpligtig mærkning i kemilokalet
Få styr på kemikalieskabet med mærkning og korrekt sikkerhedsskiltning. Vore labels er resistente overfor kemikalier og tåler nitrogen, nedfrysning, vandbad og autoklavering - perfekte til kemilokalet.
Køb en handy håndholdt labelprinter i dag og få orden i sagerne.

Laboratorieprinter, startpakke
Alt du skal bruge for at kunne mærke kemikaler og andet materiel i laboratoriet med tekst og advarselssymboler. Robust M210 printer, der tåler stød og fald. Design, skab og udskriv via et intuitivt tastatur og ved hjælp af forskellige symbolkategorier i menuen. Genbrug og tilpas labels, der er gemt lokalt på printeren, og opret fra bunden med indbyggede guider til labeldesign.
Labels sidder fast og bliver siddende på overflader, og de kan modstå kulde, varme, fugt, vejrforhold og meget mere. Der fås ark med tekniske data til alle materialer.

NYHED
Brady M611
Stødsikker op til 1,8 meter. Gem data filer på USB drev eller del label-filer melem forskellige printere. Kan tilsluttes PC via USB eller op til 5 smartphone-enheder via app'en "Express Label App". Printer i sort/hvid.



NYHED
Labels til M611
Multianvendelig, permanent labeltape i vinyl, der er både varme-/kulde-, samt kemikalieresistent.

25 mm x 15 m
48 mm x 15 m
Kittel til voksne
Hvid laboratoriekittel i god, kraftig bomuldskvalitet, med trykknaplukning, brystlomme og 2 sidelommer. Fås i størrelse small, medium, large og x-large.


Sikkerhedsluffe
Lavet af silikonegummi og temperaturbestandigt fra -50 °C til 250 °C. Den bedste beskyttelse mod varme og kolde overflader.
NYHED

Justerbare sikkerhedsbriller
Ultralet sikkerhedsbrille (34 g) med stænger, der kan justeres i længde og vinkel og dermed give optimal pasform. Linser i klar slagfast polycarbonat med overfladehærdet antirids og integrerede sidekapper. CE, EN166 og EN170 godkendt.


Børnekittel, str. 122 - 158
Endelig også til børn: laboratoriekitler til børnehave eller grundskole i 100% bomuld med brystlomme, 2 sidelommer og knaplukning. Beskytter tøjet fra de små "forskere" og "kunstnere" mod blæk og kemikalier. Fås i mange størrelser.

Ansigtsvisir, 10 stk.
Engangsartikel, der smides væk efter brug - man kan dog afspritte skærmen til genanvendelse. Ansigtsskærmen kan bæres sammen med beskyttelsesbriller og alm. briller. Kan justeres til både børn og voksne. Ansigtsskærmen er gennemsigtig og synsvinklen er meget bred. Oplagt til brug i uddannelsesinstitutioner, i laboratoriet m.m..
64
Minicentrifuge



Stort sortiment af bioteknologiskudstyr
Magnetomrørere med og uden varme, mikrocentrifuger og vortex-mixere
- alle maskiner er i et funktionelt og
moderne design – maskiner behøver jo ikke at være kedelige at se på.
De fleste er med LED-display og
mange nyttige applikationer, timer, visning af hastighed mv.
Magnetomrører
u/ varme
Magnetomrører m/varme, max. 10 liter
TILBUD

KR. 2.383,-
SPAR 25%
Magnetomrører
u/ varme
Vortex mixer


- variabel hastighed

65
Adam-vægte
Se tekniske detaljer og vores fulde program af vægte på scandidact.dk/naturfag
CB - serien
En kompakt transportabel vægt, som er velegnet til en bred vifte af anvendelser. Med sin kompakte størrelse er den nem at finde plads til. Klar og tydelig aflæsning af resultater på LCD-display . Rustfri stålplatform, der er aftagelig for nem rengøring. Måleenheder: gram, ounces og pund. Netledning kan tilkøbes.
Kapacitet: 500 g
Vejeinterval: 1 – 500 g
Nøjagtighed 0,1 g

CQT - serien
FLERE VARIANTER
Core - serien en er det rigtige valg, hvis du værdsætter enkel betjening og ”værdi for pengene”. Vægten er konstrueret til at modstå brugen i uddannelses-laboratorier, være let at rengøre og samtidig være beskyttet mod utilsigtede udslip. Med indbygget ShockProtect ™ beskyttelse, håndterer vægtene store overbelastninger uden problemer.
Kapacitet 600 g, præcision 0,1 g Kapacitet 200 g, præcision 0,01 g
HCB - serien
Har hvad det kræves for laboratoriearbejde, feltbrug, og med mange forskellige uddannelses- og industrielle applikationer.
Kapacitet: 1000 g
Vejeinterval: 0,01 – 1000 g
Nøjagtighed: 0,02 g 5 forskellige vejeenheder.
PGW – serien
FLERE VARIANTER
- kan alt hvad en laboratorievægt skal kunne og mere til.
Kapacitet: 450 g




Vejeinterval: 0,001 – 450 g
Nøjagtighed: 0,002 g
66
Bord- og præcisionsvægte
Som Premium Consulting Partner hos tyske KERN er Scandidact klædt på til at vejlede jer i investeringer i vægte, mikroskoper og lign

Model PCB varenr. SKU22
Præcisionsvægt/bordvægt fra PCB-serien, max. vægt fra 0,1-10 kg
Model EMB varenr. SKU21

Startklar begyndervenlig vægt, der bruger justeringsprogrammet CAL.
De fleste vægte kan købes med kalibreringscertifikat og kan naturligvis serviceres hos Scandidact. MEST
Model PNJ varenr. SKU125




Præcisionsvægt / laboratorievægt i højeste kvalitet fra KERN med tællefunktion - ideel til mobilt brug.
Model EWJ varenr. SKU124
Laboratorievægt i højeste kvalitet fra KERN med høj præcision.
67
Model Max.
Nøjagtighed Vejeplade, mål (mm) PCB 350-3 350 0,001 Ø81 PCB 2500-2 2500 0,01 130mm x 130 PCB 3500-2 3500 0,01 130mm x 130 PCB 6000-1 6000 0,1 150mm x 170 PCB 6000-0 6000 1 150mm x 170 PCB 10000-1 10000 0,1 150mm x 170 Model Max. vægt (gram) Nøjagtighed Vejeplade mål (mm) Pris EMB 100-3 100 0,001 170 x 240 x 54 EMB 200-3 BESTSELLER! 200 0,001 170 x 240 x 39 EMB 600-2 600 0,01 170 x 240 x 39 EMB 2000-2 2000 0,01 170 x 240 x 54 EMB 500-1 500 0,1 170 x 240 x 39 EMB 2200-0 2200 1 170 x 240 x 39 EMB 5.2K5 5200 5 170 x 240 x 39 Model Max. vægt (gram) Nøjagtighed Vejeplade mål (mm) Pris PNJ 600-3M 620 0,001 Ø140 PNJ 3000-2M 3200 0,01 190 x 190 PNJ 12000-1M 12000 0,1 190 x 190 Model Max. vægt (gram) Nøjagtighed Vejeplade mål (mm) Pris EWJ 600-2SM 600 0,01 Ø120 EWJ 600-2M 600 0,01 Ø120 EWJ 6000-1SM 6000 0,1 155 x 145 EWJ 6000-1M 6000 1 155 x 145
vægt (gram)
En investering i et KERN-produkt sikrer jer den højeste kvalitet og en funktionalitet i absolut verdensklasse.
SOLGTE
Model ODC-9

Dette håndholdte mikroskop arbejder som et digitalt overfladekamera og forstørrer genstande fra 10 til 200 gange.
Tag billeder eller videoer og mål prøverne, som du kan se med det samme på din smartphone eller tablet (iOS eller Android). Mikroskopet er med WIFI og er nemt og sikkert at håndtere. De indbyggede højtydende hvide lysdioder (6 stk) kan belyse objektet uden brug af ekstra lys.
Har rigtig mange muligheder og kan anvendes af mange forskellige aldersgrupper.
I TVIVL? FÅ ET UDVALG
Stereolup SC – 133
Trinløs zoom stereolup med 360° drejeligt hoved og LED belysning. Trinløs forstørrelse fra 0,7 mm til 4,5 mm (7x til 45x). Selvfølgelig monteret med overbelastningssikring.

Specifikationer
• Okular: WF10x / 22 mm
• Binokulær tubus: 45° hældning, med dioptri kompensation på et tubus.
• Hoved: Binokulær, 360˚ drejelig
• Pupilafstand: 50 mm til 76 mm justerbar
• Zoomobjektiv: 0,7 x til 4,5
• Forstørrelse: 7x til 45x (trinløs)
• Arbejdsafstand: 100 mm

• Fokusering: fokuserende drejeknapper på begge sider
• Højdejustering: Tandstang med tilspændingsskrue.
• Belysning: Variabel LED oven – og / eller underbelysning, svarende til 20W og 15W halogen
• Tilslutning: 230V - overbelastningssikring
• Aftagelig ledning
Dækglas
Mål: 18x18 mm. Pakke med 100 stk.


Diatec – ramme
Med cirkelformet, vandtæt kammer. Æske med 5 stk. Mål: Ø22 cm, H10 cm.
68
PÅ PRØVE HELT GRATIS!
Polarisationsmikroskop, trinokulært
Polarisationsmikroskopet er særligt velegnet til observationer, der kræver gennemlysning, eks. sten-slides. Med 40x, 100x og 400x forstørrelse og justerbar halogenbelysning 6v-20W.

Specifikationer:
• Okularer: WF 10x/18 mm (par), et med viser, justerbar pupilafstand 48 - 75 mm

• Rør: 45° skråtstillet, ikke roterbar, med dioptrikompensation på et rør +/- 5 dioptrier. Tredje rør til foto- og videooptagelse

• Næsestykke: tredobbelt
• Objektiver: DIN akromatisk 4x, 10x, 40x (fjederbelastet). Positive klikstop forsynet med ribbede greb for nem rotation monteret på en kuglelejemekanisme for jævn og præcis justering
• Fokusering: koaksiale kuglelejeføringer, grove og fine fokuseringsknapper på begge sider
• Objektbord: drejeligt og rundt objektbord med skala. Ca. Ø: 125 mm med fine novergrader. Forsynet med sceneklemmer til fastholdelse af prøven.
NYHED

• Fast kondensator: Abbe kondensator N.A. 1.25 i centrerbar holder, justerbar i højden gennem tandstang og tandhjul. Kondensatoren har filterholder, aftageligt blåt filter og indbygget irismembran
• Belysning: Indbygget, justerbar halogenbelysning 6 V/20 W
• Forstørrelser: 40x, 100x, 400x
• Strømforsyning: 240 V/50 Hz med sikring
Kamera
To gode kameraer med henholdsvis 3 og 5 megapixels og USB 2.0. Kan bruges på de fleste stereolupper/mikroskoper vha. medfølgende adaptere.


Monokulært mikroskop
Mikroskop udstyret med objektbord og let betjent præparatclips. 360° drejelig hoved og 45° okulartubus, der giver en behagelig synsvinkel. Forstørrelse: 40x, 100x og
400x
Se alle tekniske detaljer på scandidact.dk/naturfag.

69
Sandsten
Skifer
Basalt
Mikroskoper
Model SC- 25

Mikroskop i et flot design med dioptrijustering, brugervenligt og med den nyeste LED teknologi. Objektbord og 45° okulartubus, samt krydsbord og 360° drejeligt hoved. Velegnet til undervisning på gymnasie-niveau.
Specifikationer
• Forstørrelser: 40x, 100x, 400x og 600x, kan udvides helt op til 1500x
• Objektiver: DIN akromatisk 4x, 10x, 40x og 60x (fjederbelastet)
• Okular: 10x vidvinkel.
• Monokulær tubus: 360˚ drejelig
• Revolver til 4 objektiver.
• Fokusering: Dobbelte koaksiale med grov- og finindstilling.
• Objektbord: Krydsbord/objektfører med koaksiale kontrol. XY justering gennem ergonomisk korrekt placeret knapper.
• Præparatstop: Til sikring mod utilsigtede hændelser af mikropræparater ved fokusering.
• Fast kondensor: Abbe kondensator NA 1,25 med i risblænde, kan justeres i højden
• Belysning: Ny generation power LED 1 W. Lysstyrken kontinuerligt justerbar via potentiometer. Lysudbytte kan sammenlignes med 20W halogen.
• Levetid LED: ca. 50.000 timer
• Driftsspænding: 90~240 V / 50 Hz
Monokulært (SC-120)
Hånd- og bordmikrotom
Praktisk håndmikrotom/bordmikrotom med justeringsgrad på 10 microns per klik. Leveres i flot trææske komplet med mikrotomkniv og skruetvinge.
VORES MEST POPULÆRE MIKROSKOP!
Binokulært (SC- 25)
Præparatfarver, sæt
Farvesæt til mikroskopi i trådkurv. 9 forskelige væsker og farver, samt en tom flaske. Det hele leveret i praktisk plastbelagt trådkurv og 30 mL pipetteflasker.
Trinokulært (SC-130)
Objektglas
Objektglas med afslebne kanter.
Mål: 76 x 25 x 1 mm.

Pakke med 50 stk.
 Blomsterstilk (Dahlia)
Blomsterstilk (Dahlia)
Spar på ressourcerne - med Johnny og Scandidact!


Vores pakketape er lavet af papir, så vores foresendelser kan nu gå direkte i papirgenbrug, i modsætning til til papkasser med PVC-tape og metalklammer.
For at sikre, at vore forsendelser ikke går i stykker, kunne vi bruge metervis af skum og bobleplast. Det har vi valgt fra. I stedet genbruger vi pakkefyld og papkasser, som vi får fra vore leverandørerja, selv vore medarbejdere tager pap og fyld med på arbejde til genanvendelse. På den måde gør vi vores til ikke at rutte alt for meget med ressourcerne.
Vores BIO pakkefyld er 100% kompostérbart og fremstillet af GMO-frit, CO2neutralt majsstivelse produceret lokalt i Danmark. Fyldet opløses i vand på få minutter - brug det i komposten eller bland det i pottejorden!


Vi har minimeret antallet af vores tryksager og vælger tit den miljørigtige onlineversion. Vores årlige katalog trykkes på Svanemærket papir, som er fremstillet energieffektivt, og som lever op til skrappe krav til kemikalier - både i skoven og i trykkeriet. Endvidere er papiret lavet af lovligt, sporbart træ, hvor en andel er certificeret – og/eller af genbrugspapir.
Som en ekstra lille “glorie-pudser”, sendes vores Scandidacts vejledninger ikke sammen med produktet ved køb. I stedet er alle vejledninger nu frit tilgængelige i webshoppen (f.eks. om mikroplast, sten og bjergarter, enzymer, vandrensning, CRISPR-teknologi, kombucha, bestrålede frø, majsfrø, UVperler, biogasanlæg, chromosomer m.m. - og flere er på vej!).




En gave til jer og ikke mindst miljøet. Det var så lidt


ER
DER

NOGET, DU MANGLER?
Med mere end 5.000 varenumre har vi sikkert det, du lige står og mangler - hvis ikke, så kan vi sikkert skaffe eller udvikle det.

Kontakt os og hør mere: br@scandidact.dk eller tlf. 4913 9333.

Scandidact ApS
Skovdalsvej 4 · 8300 Odder info@scandidact.dk www.scandidact.dk/naturfag
Tlf. (+45) 4913 9333
541-856 Svanemærket
Grafi
Vi
tager forbehold for trykfejl og udsolgte varer. Opdaterede og gældende priser kan ses i vores webshop. Alle salgspriser er ekskl. moms og transportomkostninger. Se vores øvrige sortiment på www.scandidact.dk/biologi
tryksag
sk produktion: BRUHN Grafi sk ApS

Blomsterstilk (Dahlia)
Blomsterstilk (Dahlia)